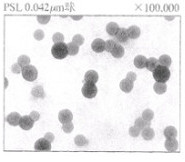
基板上固体の液中付着性解析

ミニセミナー・基礎講座
濡れ・気泡・付着・表面処理
目次
液滴の濡れ性
接触角をエネルギー的に解析する

濡れを考える場合、液滴の接触角はよく用いられる手法である。この接触角θとはどのような意味を持っているのだろうか?あるいは、どのように使うべきなのか?ここでは、基本原理に立ち返り、本質的な接触角の特性を考える。さて、濡れは面と面との接触における基本概念であり、コーティングや材料合成分野でも重要となる。濡れの概念は液体だけでなく、固体や膜表面においても共通の概念である。材料科学では、濡れと乾燥は、大きいエネルギー変化を伴う現象として理解できる。濡れは熱力学的な平衡状態に基づき基礎理論が構築されている。ここでは、平面での液滴の濡れ挙動を示す基本式として、Youngの式とDupreの式について述べる。
固体基板上での液滴の濡れ性を表す指標に、接触角θがある。接触角法は、測定が簡単であり、汎用性の高い測定法の一つである。液滴の接触角は、接触角計(ゴニオメーター)で測定できる。最近は高精度のマイクロスコープが登場しているため、これを用いた投影測定で十分である。接触角計の誤差は1度以下であり、測定者の差が出にくい長所がある。液滴の接触角は、右上図にあるように、液滴を球の一部として仮定した場合、立体球の中心角の半分に相当する。熱力学な定義では、この液滴球の中心角としての定義が本質であり、右下図(a)にあるような実験的に得られる接触角は、幾何学的に等価な角度にすぎない。固体平面での濡れ性を表す関係式に、以下のYoungの式がある。
γSV = γSL + γLV cosθ ; cosθ=(γSV - γSL)/ γLV (1)


右下図(b)にあるように、Youngの式は、固相(S)、液相(L)、気相(V)の3重点において、液滴と固体の表面エネルギーγLV、γSVと液滴と固体間の界面エネルギーγSLで表される。これらは物質の表面有する単位表面積あたりのエネルギー(J/m2)として表される。このときのVはvapor(蒸気)を表しており、接触角測定は液滴の飽和蒸気圧下で行うことを意味している。これは、後述の接触角の経時変化において大きく影響することになる。Youngの式を、3重点における力学的な釣り合いの式として説明する著述が見られるが、これは正しくない。Youngの式は、液滴球の中心角を基本とした表面積および界面積の導出と、各エネルギーのバランスに基づいて導出される。ここで、親水性(θ=0度、cosθ=1)と疎水性(θ=90度、cosθ=0)表面を考える。θ=0度とは、γSV=γLV、(ただしγSL=0)となり、これは親水性を示している。この式から、親水性表面を得るには、基板と液滴の表面エネルギーを近づけるとともに、界面エネルギーを最小にすることが必要である。いわゆる同じ材質同士であれば良く濡れることを表している。逆に、θ=90度とは、(γSV-γSL)<<γLVとなることであり、これは疎水性の濡れ性を示している。疎水性表面を得るには、液体の表面エネルギーを固体よりもできるだけ大きくし、界面エネルギーも増大することが必要となる。Youngの式から、表面エネルギーが同じ値の表面間の組合せであっても、接触角はゼロにならないことが分かる。これは界面エネルギーがゼロではないからである。界面エネルギーをゼロにするには、各物質の表面エネルギーが等しいだけでは不十分である。このためには、表面エネルギーの成分(分散、極性)を等しくすることが必要となる。これら成分の取り扱いについては後述する。以上のように、Youngの式を用いることで、身近な濡れ性を説明することができる。
界面での液滴の濡れ性を議論する上で重要な関係式として、以下のDupreの式がある。
Wa =γSV+γLV-γSL

この式は、右図に表されるように、界面が2つの表面へ分離する場合のエネルギー収支に基づいている。ここで、Waは界面を分離するために必要なエネルギー(J/m2)であり、剥離エネルギーと呼ばれる。エネルギーの損失がなければ、Waは付着エネルギーに相当する。また、液滴と固体表面の場合は、濡れエネルギーとして扱われる。以上のYoungの式とDupreの式を組み合わせることで、以下のYoung-Dupreの式が得られる。
Wa =γLV (1 + cos θ) (2)

この式を用いることで、実験的に濡れエネルギーを求めることができる。
液滴の濡れ性を議論する場合、接触角θの値をそのまま用いるケースが見られる。しかし、接触角だけでは物理的な議論が困難である。少なくとも、(1)式および(2)式を用いて、濡れエネルギーWaとして、現象を解析することが望ましい。右表にあるように、接触角θが0~10度の範囲で変化しても、濡れエネルギーは0.8%程度しか変化していない。よって、接触角が2倍変化しても、表面特性が倍増して変化することにはならない。すなわち、接触角が低い親水表面の場合では、大きい現象変化は見られないことを示している。逆に、接触角が80~90度の範囲となる疎水表面では、濡れエネルギーは17%変化しており、大きい現象変化とみなされる。同じ接触角の変化量であっても、エネルギーの変化としては大きい隔たりがある。以上のように、液滴の濡れ性および付着性を議論する上で、これらの式は基本となる。
固体上での液滴の接触角について、代表的な理論式に基づいて説明した。また、接触角の取り扱いにおける実験的なノウハウについても言及した。コーティング剤などの塗布において、このように濡れエネルギーとして定量化することで正確に理解できる。
参考文献
- Swalin, 上原他訳, 「固体の熱力学」 コロナ社 , p.88 (1992).
- Israelachivili. J. N ; Intermolecular and Surface Forc, 2nd Edition, (Academic Press).
- D. H. Kaelble, J. Appl. Polym. Sci., 18, 1869 (1974).
表面粗さと素材割合によって接触角は変化する



固体表面に液滴が触れると、右図のように接触角が形成される。液滴の接触角は、表面エネルギー、や濡れ仕事といった表面の熱力学的なエネルギー収支を反映している。ただ、この接触角は、固体表面の物理量の簡単な測定手法としても有効である。具体的には、固体の表面積や面積割合が、精度高く計測できる。これには、Wenzelの式とCassieの式といった関係式を用いる。これらの式は、Youngの式と並んで固体表面の濡れ性の基本式である。
液体の濡れ性は、固体表面の粗さに敏感である。粗面の濡れ性は、以下のWenzelの式で表せる。
cos θw = r cos θ
ここで、θwは粗い面上での接触角を表し、θは同じ材質で平坦面での接触角を表す。rは平面に対する粗面の面積比(r≧1)を表す。表面が粗いほど、面積比rは増大する。この面積比に対して、右図のように、濡れ特性を図示できる。Wenzelの式は、θ<90度ではθw<θとなり、θ>90度では、θw>θとなることを示している。すなわち、表面粗さが増加するにつれて、親水性表面では接触角が小さくなり、疎水性表面では接触角がさらに増大する。接着剤や半田付けのように、表面が粗いと濡れやすい現象は、この関係式に基づく。よって、これらのデータベースを構築すれば、下式のように固体の表面積測定が可能となる。
r = cos θw / cos θ
接触角測定の液滴直径は数ミリメータ程度であり、平均的な面積増加率としてrが求まる。一般に、固体の表面積の計測は、レーザー方式や触針式の粗さ計などが用いられる。しかし、このWenzelの式を用いることで、精度高く表面積を測定できる。
一方、右図のように、異なる材質Aと材質Bで構成された複合表面を考える。Aの材質が占める面積割合をσとする。このとき、複合表面での接触角θcは、以下のCassieの式で表される。
cos θ c = σ cos θA + (1 -σ) cos θB


ここで、θAおよびθBは、A基板およびB基板だけでの液滴の接触角である。上の左図および右図は、面積割合σの変化に対する接触角変化を示している。Cassieの接触角θcは、材料の面積割合σに直線的に変化する。よって、下式のように、素材の面積割合σを求めることができる。
σ =(cos θc - cos θB)/(cos θA - cos θB)
通常、材料の面内分析はEPMAやXPSなどの高価な設備を用いる場合が多いが、Cassieの式によれば面積割合を簡単に求めることができる。
以上のように、接触角測定により、固体表面の物理情報を精度良く簡単に求めることができる。
参考文献
- R. N. Wenzel, J.Phys., Colloid Chem. 53, 1466 (1949).
- A. B. D. Cassie, Disc. Faraday Soc., 3, 11 (1948).
撥水表面は濡れにくい
コーティングプロセスは、塗工液の濡れに始まり成膜乾燥で完結する。液滴の濡れ挙動はコーティングプロセスの初期に決定されるため、濡れトラブルや塗膜欠陥も初期プロセスで発生しやすい。一般に、濡れコントロールは、塗工液と基板との界面相互作用が基礎となる。基板上の濡れ性解析は洗浄・乾燥・接着におけるトラブル低減に効果がある。ここでは、塗工液の濡れに関する様々なトラブルに注目し、その発生メカニズムを考察する。具体的に、液滴ポッピングなどを紹介する。


(接触角θ=150°)
液滴の濡れは基板と接触後の短時間で決まる。そこで、上図は、シリコン基板上に純水液滴を滴下させた時の様子を示している。高速度カメラを用いた測定によると、液滴形状および接触角は、基板と接触後から9 msまでは大きく変化する。そして、20 ms経過後には液滴は安定した濡れ性を示す。接触角の測定は安定した液滴の形成後に可能となる。しかし、液滴と基板との接触が失敗すると、液滴はポッピングを起こし所望の位置に濡れなくなる。塗工液の濡れ性が低い条件では、初期の濡れが成立しない場合がある。右図は、超撥水基板上に滴下した純水液滴の濡れ現象を示している。この時の接触角は150°である。液滴は球形になるように撥水しているが、濡れにくい基板上ではポッピングが生じやすくなる。実際には、純水接触角が90°を超える疎水表面では、塗工液が濡れにくくコーティング不良を生じやすい。ここでは、これらの濡れ性を表面エネルギーで考察する。表面エネルギーγは、分散成分γdおよび極性成分γpの和で表すことができる。
γ=γd+γp

右図に様々な疎水性基板の分散および極性成分を示している。超撥水基板の表面エネルギーは、分散成分γd=3.35 mJ/m2 、極性成分γp=0 mJ/m2となり、表面エネルギーγ=3.35mJ/m2である。超撥水基板では、極端に極性成分を低下し、表面エネルギーを下げるように設計されている。図中には、パラフィン表面(γd=21.1mJ/m2 、γp=0 mJ/m2、γ=21.1mJ/m2)やテフロン表面(γd=16.1mJ/m2 、γp=0 mJ/m2、γ=16.1mJ/m2)も記載している。いずれも極性成分γpが低く、かつ表面エネルギーγが低い。また、超撥水基板を作製するには、表面エネルギーを下げるだけでなく、液滴との界面エネルギーを増大させる必要がある。すなわち、右図のように、成分図上で基板と液滴のポイントを離すことが効果的である。さらに、超撥水の濡れ現象は、表面エネルギー制御だけではなく、基板表面の微細な凹凸形状が関与している。これはWenzelの式で説明できる。
cosθw = r cosθ
ここで、θwは粗い面上での接触角を表し、θは同じ材質で平坦面での接触角を表す。rは表面粗さ係数であり、平面に対する粗い面の面積比(r≧1)を表す。すなわち、平面基板で90°を超える接触角を形成する場合、表面粗さの増加に伴って接触角はさらに増大する。実際の塗膜においても、このWenzel効果が影響しているケースは多い。ここで、超撥水基板上での液滴ポッピングを考察する。下図は、超撥水基板上に滴下した水滴の挙動を示している。水滴は基板上に落下した後、濡れることなく跳ね上がるポッピング現象を示している。コーティングの場合、塗工液は基板上の初期位置で濡れなくなる。

さらに、下図のような傾斜基板では、液滴はポッピング後に他の位置へ移動する。これらは、インクジェット印刷などの高精細コーティングにおいて重要な問題となる。この液滴ポッピングは、スピンコートなどの回転基板上への滴下時にも生じる。液滴の濡れエネルギーよりも、落下の運動エネルギーや基板回転時のせん断エネルギーが上回る場合にポッピングが生じる。また、フライパンの油膜上で水滴が跳ね上がるメカニズムも同じである。コーティング時のポッピングを防ぐには、塗工液および基板の表面エネルギーの最適化の他に、濡れエネルギーを超える運動エネルギーを塗工液に付与しないことが大切である。

ここでは、コーティングにおける塗工液の濡れトラブルおよび要因解析について概説した。塗工液の濡れはコーティング膜形成の基本となり、塗膜の品質に大きく影響する。また、液滴ポッピングなどの濡れに関するトラブルを紹介し、その要因および解決策を紹介した。これらの濡れトラブルは、特殊なケースではなく、通常のコーティングプロセスにも生じやすい。
参考文献
- P.G.Saffman and G.I.Taylor, Proc. Roy. Soc. A245 312 (1958)
- Akira Kawai,"Viscous finger pattern formed in photoresist film during heat treatment", J. Photopolymer Sci. Technol, 17, 103-104 (2004).
- Akira Kawai, "Pinning effect of micro drops on geometrical complex substrates composed with different surface energy materials", J. Vac. Sci. & Technol. B22(6), Nov/Dec 3525-3527 (2004).
濡れ挙動は分散極性と拡張係数で説明できる
表面エネルギーはコーティング、濡れ、付着・剥離などの表面利用技術の基本となる物理量である。これらは、Youngの式などの基本式により、定量的に説明できる。ここでは、接触角計を用いた固体および液体の表面エネルギーの測定方法と利用技術について述べる。表面エネルギーは、分散成分と極性成分の和として表すことができ、これらの成分には表面の化学的性質が反映されている。さらに、コーティング膜や微粒子の溶液中の付着性を議論できる拡張係数Sについて述べる。また、表面処理を行うことで、表面エネルギー成分を変化できる。O2プラズマ処理とシランカップリングなどの様々な実用的な表面処理技術を紹介する。
固体および液体には有限の表面エネルギーが存在しており、それが変形や亀裂などの力学的仕事、酸化や汚染などの化学的反応として消費される。金属などの固体の理想的な表面エネルギーは2000~3000mJ/m2であるが、酸化層、汚染層、吸着水などの表面層形成により、100mJ/m2以下に低下する。ここで、表面エネルギーの低下は表面の安定化を意味している。表面層の厚さは通常4~5nmである。この表面エネルギーが付着やコーティングといった機能的な仕事をする。表面エネルギーは、分散成分γdおよび極性成分γpの和として表される。
γ=γd+γp

分散成分は物質の密度、分子量、硬さなどが反映した物理量であるが、その大小関係は逆である。酸化物や金属の分散成分は低いが、有機材料の場合は高くなる。また、極性成分は、表面の極性基密度や活性度をそのまま反映している。固体および液体の分散成分は「ゼロ」にならないが、極性成分は「ゼロ」になりうる。ここで、各成分を表面同士の分子間相互作用で考える。右図に示すように、分散成分は2個の無極性分子(双極子)間のクーロン引力として表され、London分散エネルギーと呼ばれる。一方、極性成分は、永久双極子間(Keesom)及び、永久双極子-無極性双極子間(Debye)エネルギーとして定義される。これらの成分は、以下の式によって表される。
![]()
ここで、r は双極子間距離、αは分極率、u は双極子能率、Tは温度である。極性成分は温度Tに反比例することが分かる。たとえば、水の表面エネルギーは室温では72.8mJ/m2であるが、80℃では62.6mJ/m2に低下する。温水での洗浄効果が上がる理由は、この極性成分の低下が理由である。一方、大気などの気体の表面エネルギーは実態がないため「ゼロ」として扱い、後述の成分図上では原点が気体に相当する。
物質の表面エネルギーの分散および極性成分の測定法について述べる。固体(S)と液体(L)との付着エネルギーWaは以下となる事を述べた。
Wa = γS + γL - γSL = γL(1+cosθ) (1)
ここで、θは固体表面での液体の接触角である。また、付着エネルギーWaは、表面間の相互作用として、各成分間の二乗平均として表せる。
![]()
よって以下のYonng-Dupreの式が得られる。
![]() (2)
(2)
ここで、両辺を![]() で割る事により下式のように変形できる。
で割る事により下式のように変形できる。
 (3)
(3)


まず、(3)式を用いて、未知である固体の表面エネルギー成分を求める。最初に、分散および極性成分が既知である液体を用いて、固体上の接触角を測定する。液体には、極性成分の高い純水と分散成分の高いヨウ化メチレンを用いる。これらの液滴の分散および極性成分を右表に示している 。よって、式(3)に基づくと、右図のプロットが得られる。図の切片より固体の表面エネルギーの分散成分γSdが得られ、傾きから極性成分γSpが得られる。また、得られた成分の和として、固体の表面エネルギーγsが求まる。下図(a)は、この手法で求めた表面エネルギーの成分図を示している。横軸に分散、縦軸に極性成分をとり、図中の1点は物質の成分値を表す。ここでは、実際に測定したSiO2膜(TEOS)の成分値を示している。液体として、純水、ヨウ化メチレン、エチレングリコールも示している。SiO2膜と純水の極性成分が高いが、ヨウ化メチレンなどの有機溶剤の分散成分は高いことが分かる。

次に、未知の液体の表面エネルギー成分を求める手法を述べる。ここでは成分が既知の固体としてパラフィンを用いる。パラフィンの表面エネルギーは24.4mJ/m2であり、極性成分が「ゼロ」であるために、分散成分もγSd=24.4mJ/m2となる。よって(2)式の右辺の第2項は「ゼロ」となり、以下の式が得られる。
![]() (4)
(4)
パラフィン膜上で液体の接触角θを測定し、表面張力計でγLを測定することにより、(4)式から液体の分散成分γLdが求まる。極性成分γLpは、表面エネルギーγLから分散成分γLdを引いて求まる。このようにして求めた液体の表面エネルギー成分値を上図(b)に示す。ここでは、純水にメタノールを重量wt%で混合した場合の成分値の変化が分かる。Si基板やTMAH水溶液(強アルカリ現像液)、樹脂系高分子、Cuメッキ膜表面の成分値も示している。
ここで(2)式を変形すると、以下のように界面エネルギーγSLが求まる。
![]()


これは、右図のように、成分図を平方根でプロットすると、界面エネルギーγSLは2点間の距離として定義できる。また、原点からの距離は、それぞれの表面エネルギーに相当する。この図において、原点を中心とした同じ円周上の物質は同じ表面エネルギーを有することとなる。しかし、その分散および極性成分は異なる。以上のように、接触角法により、物質の表面エネルギーの分散成分と極性成分を求める事ができる。
固体上を液体が濡れ拡がる時、大きく2つの濡れモードに分けられる。それは拡張濡れと付着濡れである。右図は、これらの濡れ挙動を図示している。拡張濡れの場合、基板に接触した液滴は、基板表面を限りなく拡がり薄い液膜を形成する。この場合、接触角を形成せずθ=0である。一方、基板表面で有限の液滴の接触角( θ>0)を形成する場合を付着濡れと呼ぶ。これらの濡れ現象は、以下の拡張係数S(mJ/m2)で表される。
-S = γ12 - γ13 - γ23 (5)
この場合、下図(a)のように、添え字は基板(1)、大気(2)、液体(3)となる。2つの濡れモードは拡張係数Sの符号によって区別され、S<0の場合は拡張濡れとなり、S>0の場合は付着濡れとなる。(付着濡れのエネルギーは、(1)式に従う。)ここで、(5)式を変形すると以下の(6)式が得られる。

 (6)
(6)
そして、S=0とおくと以下のような円の式となる。


この式は、下図(a) のように平方根の成分図で円として表される。円周上はS=0の成分値を表す。基板上を塗液が拡がる現象は、すでに存在する気体と基板との界面に塗液が侵入するモデルとして扱う。そこで、基板(1)と大気(2)の点を直径とする円を描くと、式(6)で表される円が描ける。液体である塗液(3)の成分値が円内にある場合は、S<0となり拡張濡れとなる。よって、塗液は基板と大気との界面に浸入し自ら拡がる。これは、清浄なガラス基板上をアルコールが拡がる場合や、LB膜が水面を単分子膜で展開する現象として知られている。また、下図(a)のように、塗液の点が円外にある場合は付着濡れモードとなり、塗体は有限の接触角を有した液滴を形成する。ほとんどのコーティングは付着濡れモードである。実際の塗液の成分値を右図に示す。有機溶剤を多く含む塗液は分散成分が高くなり、そのままでは円内に入らないため、金属やガラス表面などの無機基板上では拡張しない。塗液の成分値を円内に入れるには、下図(b)のように界面活性剤などを添加して極性成分を下げる場合と、プラズマ処理などにより基板の極性成分を高めることが効果的である。右図の例では、O2プラズマ処理を行うことで、無機材料基板の極性成分が増加したため、塗布液の成分値が円内に入っている。このように、表面エネルギー成分図を用いることで、塗液のコーティング性の制御方法が説明できる。

基板上の塗液の広がりは、下図のように、液中での気泡の除去性にも適用できる。有限の体積の大気が気泡であるため、(6)式がそのまま適用できる。すなわち、液体の成分値が円内に入れば、気泡は基板から遊離する。また、円外であれば気泡は除去されない。以上は熱力学的な取り扱いであるが、超音波振動などの外部エネルギーを印加すると気泡は除去される。微小気泡の付着性コントロールは、メッキプロセス、洗浄、撹拌、発泡、ウェットエッチングなどの様々な産業的分野において重要である。

拡張係数の理論は、液中でのコーティング膜や微粒子の付着性に応用できる。液中あるいは高湿度下での塗膜の剥離は、上の左図(a)のように、基板(1)と塗膜(2)間の界面に液体(3)が浸入することを意味する。上の左図(b)のように、基板上に付着した微粒子についても同様に取り扱える。解析手順は、下図のように、基板と塗膜を直径とした円を描き、そこに液体の成分値が円内に入るか否かで判断する。ここでは、上の右図のようなPSL(ポリスチレンラテックス)粒子の除去性を検討する。PLS粒子は形状や大きさが揃っており、標準粒子として用いられる。右図にあるように、ガラス基板上に付着したPSL粒子は純水などの液体によって除去できる。しかし、Si基板やHF処理をしたSi基板では、円内に液体の成分値は入らないため、粒子の除去が困難になる。


物質の表面エネルギー成分は、シランカップリング処理やプラズマ処理などの表面処理を組み合わせる事で幅広く制御できる。ここでは、Al膜上の微細高分子パターンの付着性に注目し、複合処理による表面エネルギー制御を行う。 上図の写真は 、線幅0.6ミクロンの高分子ラインパターンを示している。高分子膜の主成分は、クレゾールノボラック樹脂である。基板は、スパッタリングで作製したAl膜である。上図(a)は、パターン付着性が良好である。しかし、上図(b)は、パターン剥離が生じている。パターン剥離は、強アルカリ水溶液中でのパターン現像中に生じる。下表は、Al膜の表面処理による高分子パターンの付着性を示している。Al膜形成後の1回目の表面処理(1st)と、引き続いて2回目(2nd)の処理を行っている。ヒストグラムとして、剥離したパターン数を表している。ヒストグラム(黒)は現像液としてTMAH(テトラメチ ルアンモニウムハイドロオキサイド)2.38%水溶液を用いた場合であり、ヒトグラム(白)は添加剤を含んだ場合を示している。表面処理のないAl膜表面では、約100チップのパターン剥離が生じている。しかし、O2プラズマ処理をしたAl膜表面では、300チップ以上の剥離が生じており、表面処理の影響が顕著である。また、アルカリエッチングの場合は、表面処理のない場合とほぼ同等である。シランカップリング処理として、ヘキサメチルジンラザン(HMDS)処理を行った場合は、O2プラズマ処理ほどではないが、パターン剥離が増加している。以上は、成膜後のAl膜表面に1回のみの表面処理を行った場合である。さらに追加処理を行い複合させた場合を検討する。まず、O2プラズマ処理を行った表面に、引き続いて HMDS処理を行った場合を考える。結果としてO2プラズマ処理のみを行った場合に比べて、パターン剥離が200チップ以下となっており改善されたことが分かる。一方、O2プラズマ処理後にアルカリエッチングを実施した場合、剥離チップ数は、100個以下となり、成膜直後のアルミ膜と同等の付着性に戻っていることが分かる 。


以上のように、アルミ膜の表面処理により、高分子パターンの付着性は大きく影響を受けることが分かる。また、複合の表面処理をする事により、付着性を回復させる事も可能である。以上のAl膜表面での高分子パターンの付着現像を表面エネルギー理論で考察する。右図には、表面エネルギーの分散 ・極性成分マップを示している。スパッタリング直後のAl膜表面にO2プラズマ処理を施すことにより、極性成分が大幅に増加することが分かる。また、HMDS処理により極性成分が、わずかに減少している。O2プラズマ処理を行ったAl膜表面にHMDS処理を行った複合処理を実施した場合も、極性成分の低下が確認できる。これらの極性成分の増減は高分子パターンの付着性と対応しており、極性成分コントロールが有効である事が示されている。
ここで、Al膜表面にアルカリエッチング処理を行った場合に注目すると、O2プラズマ処理を実施した場合と同様に極性成分が大幅に増加している。しかし、アルカリエッチング処理により、高分子パターンの付着性は良好である。これは、Al膜表面に形成された自然酸化膜の影響によるものである。Al膜の自然酸化膜は、ポー ラスな構造をしており、弱結合層(WBL;weak boundary layer)として界面付着性を低下させることが知られている。アルカリエッチング処理による付着性の改善は、WBLの除去による効果が大きい。以上のように表面層を形成しやすい金属膜と高分子材料との付着性は、表面エネルギーとWBLの両方の要因が影響することが分かる。
ここでは、接触角計を用いた表面エネルギーの分散および極性成分を実験的に求める手法を述べた。また、拡張係数Sの概念を導入することで、基板上の薄膜や微粒子の溶液中での剥離挙動が解析できる。O2プラズマやHMDSカップリング処理により、効果的に表面エネルギーの成分値を変化できる。これによコーティング性や微粒子、気泡などの付着性をコントロールできる。
参考文献
- F.M Fowkes, J. Adhesion, 4, 155 (1972).
- J. N. Israelachivili, Intermolecular and Surface Force, 2nd Edition, (Academic Press)
- D. H. Kaelble, J. Appl. Polym. Sci., 18, 1869 (1974).
- A. Kawai, et al., Jpn. J. Appl. Phys. 31, 1933 (1992).
ピンニングにより濡れは支配される

固体表面の液滴の接触角は、熱力学的な界面エネルギーのバランスに基づくYoungの式で表せる。ここでは、基板上の局所的な濡れ性の違いが、塗工液の濡れ挙動に影響するピンニング効果に注目する。具体的に、右図のようなミクロンサイズの格子状基板を作製し、液滴の拡がりに対する異方性を基板上に持たせる。これにより、基板上の液滴の平面形状は八角形や正方形に変形することとなる。まず、下図のように、格子状パターン基板上のミクロンサイズの正方形格子パターンの高さと周期を変える。パターン幅Xは、0.8、 2.5、5.0 μmの3種類であり、高さZも0.19、0.66、1.0 μmの3種類に設定した。格子状基板の表面積r1と平坦基板の表面積r2との比として定義される表面積比r (= r1/r2)は、下式に基づいて算出する。各寸法X、 Zの異なる9種類の格子パターンを作製することで、表面積比rは下表にあるように1.1~3.5の範囲で変化できる。
![]()

r ( = 1 + 2Z/X )


濡れ挙動解析に用いた液滴は、ヨウ化メチレン(γ = 48.4 mJ/m2、γd = 44.9 mJ/m2、γp = 3.5 mJ/m2)である。正方形格子パターンは、光リソグラフィ技術を用いてTEOS(Tetraethylorthosilicate, Si(OC2H5)4)膜表面に作製する。TEOS膜の表面自由エネルギーは、γs = 60.5 mJ/m2、 γsd = 16.7 mJ/m2、 γsp = 43.8 mJ/m2である。右図は各正方形格子表面でのヨウ化メチレン液滴の平面形状を示している。表面積比が小さい基板(r = 1.1、X = 5.0μm、Z = 0.19μm)では、液滴形状は円形になっている。しかし、表面積比が大きい基板(r = 3.5、X = 0.8μm、Z = 1.0μm)の場合は, 格子方向から45°回転した四角形となっている。また、ほぼ中間的な基板(r = 1.5、X = 2.5μm、Z = 0.66μm)の液滴形状は、八角形に変形している。また、ほぼ同一の表面積比rの場合は、X、Zの値が異なっても同様な平面形状を示す傾向がある。このように、基板上での液滴形状は基板の数ミクロンオーダーの形状変化を敏感に反映して変化する。下の左図は、表面積比rと液滴の平面形状における格子方向(L1)と45°方向(L2)の寸法比A( = L1/L2)との関係を示している。平面形状が円形および八角形の場合はA = 1となる。また、A ≒ 1.41は, 四角形を意味する。下の左図のように表面積比rが約1.5以上になると、液滴の形状変化が顕著になる。また, 液滴の拡張時の単位長さ当たりの格子パターン数は, 格子方向よりも45°方向が約1.4倍多くなる。よって、基板上の各格子パターンが液滴の拡張に対して抑制ポテンシャル(ピンニング)として働くとすれば, パターン配列に対して45°方向は液滴の拡がりが遅くなる。よって, r = 3.5の場合の様な45°回転した四角形が形成されると考えられる。r = 1.5の八角形は, 円形と四角形との中間状態であると考えられる。以上の液滴のピンニング現象は、下の右図にあるように、基板や版上に突起や異物、空隙、汚れなどの不連続点が存在した場合、液滴の濡れ挙動は非常に影響を受ける。ピンニングを避ける手法はほぼ無いといえるが、プラズマ処理等により版上の濡れ性を向上させれば緩和される。

基板表面積比rとの相関

ここでは、コーティングにおける塗工液の濡れトラブルおよび要因解析について概説した。塗工液の濡れはコーティング膜形成の基本となり、塗膜の品質に大きく影響する。また、液滴ポッピング、ピンニングなどの濡れに関するトラブルを紹介し、その要因および解決策を紹介した。これらの濡れトラブルは、特殊なケースではなく、通常のコーティングプロセスにも生じやすい。
参考文献
- P.G.Saffman and G.I.Taylor, Proc. Roy. Soc. A245 312 (1958)
- Akira Kawai,"Viscous finger pattern formed in photoresist film during heat treatment", J. Photopolymer Sci. Technol, 17, 103-104 (2004).
- Akira Kawai, "Pinning effect of micro drops on geometrical complex substrates composed with different surface energy materials", J. Vac. Sci. & Technol. B22(6), Nov/Dec 3525-3527 (2004).
付着剥離
塗膜の付着性と表面エネルギーの極性成分
電子デバイスなどの機能性素子には、絶縁材料、導電材料など様々な材料が用いられている。ここで、高分子材料との付着性の確保はデバイス動作の信頼性向上において重要となる。ここでは、表面エネルギー解析に基づいた付着性解析を行う。特に、溶液および大気中での特性の違いに注目するとともに、極性成分を主体にした界面設計手法を紹介する。

Si(100)単結晶基板上に、電子デバイスによく用いられる無機基板としてWsi2, Sio2, Si3N4, BPSG, PSG, Alの各膜を形成した。高分子として三菱化成工業製のMCPR2000Hポジ型高分子を、また、現像液にはTMAH2.38%水溶液を用いた。接触角法の測定の際、上表のように表面エネルギーの各成分がわかっている標準液としてグリセリン、フォルムアミド、ヨウ化メチレン、エチレングリコール、純水の5種類を用いた。付着実験フローを下の左図に示している。乾燥下で引き剥がし試験を行い、付着強度として剥離時の引っ張り強度、(kg/cm2)を用いた。試験チップとして高分子膜を約5mm×5mmの正方形の2枚の同種の無機基板で挟み、これを約300℃で5分間加熱したものを用いた。そして両端の無機基板に約1~20kg/cm2の力を分離方向にかけ、付着破壊が生じたときの力を記録した。試験機としてQuad Group社のSebastian-1を用い、実験は25℃の大気中で行った。溶液中、すなわちTMAH水溶液中での付着強度として、水溶液浸漬中に高分子パターンが剥離し始める時の時間(TD)を用いた。よってこの時間が長い程、溶液中での付着強度は強いと言える。溶液中での付着実験の試験チップとして、各基板上に光リソグラフィ技術によって形成した高分子パターンを用いた。まず、高分子膜をスピンコート法で1μmの膜厚に無機基板上に塗布形成し、これを縮小投影露光機(ニコン製1505G3A)を用いて、100μm角の正方形パターンを高分子膜上に焼き付けた。この時、HMDS(ヘキサメチルジシラザン)の様なLSI製造時によく用いられている密着強化処理は行っていない。次いで、これらのウェハをTMAH現像液中へ浸漬しパターン現象を行うと共に、パターン剥離が生じる時間を計測した。この時浸漬時間は最大2時間であった。


現像液の表面エネルギー

実験に用いた各無機基板,高分子,現像液の表面エネルギーの2成分値の測定結果を上の右図に示した。横軸には分散(α=√γd)を縦軸には(β=√γp)成分をプロットしている。PドープしたポリSi, SiO2,BPSG基板の極性値は比較的高く、一方、AlやSi基板の極性値は低い値となっている。Wsi2やMoSi2といったシリサイド膜は中間の値を示している。又、高分子膜であるMCPR2000HもA1同様の低い値を示している。これ以外の市販高分子の表面エネルギーも調べたが、ほとんど差は見られていない。TMAH現像液はBPSG膜等と同等の高い極性値を示している。分散成分に関しては極性成分程の試料間の大きい有意差は見られず、この値は材料の依存性が少ない物理量であることがわかる。ここで、単位dyn/cmはmJ/m2に相当する。
右図は、乾燥下での付着強度(FA)と表面エネルギーより求めた付着エネルギー(EA)との相関を示している。乾燥下ではAlやSi基板は低い付着強度を示すが、PSG, BPSG, PドープポリSiなどは高い付着強度を示す事がわかる。また、引き剥がし力を15kg/cm2以上にかけると無機基板が割れるなどの破壊が生じる。

上図には、この付着強度(FA)、付着エネルギー(EA)の無機基板表面の極性成分(βS)依存性を示している。基板の極性成分が増加するに従い付着強度,付着エネルギーも増加し、強い正の相関がある事がわかる。一方、下図には、同様に基板の分散成分(αS)依存性を示している。分散成分と付着挙動は殆んど相関を示さない事がわかる。よって、乾燥下での付着の挙動には基板表面の極性成分のみが大きく影響していると結論づける事ができる。


付着エネルギーとの相関
右図はTMAH水溶液中での付着強度(TD)と付着エネルギーとの相関を示している。乾燥下とは違ってAlやSi基板などは比較的高い付着強度を示すが、PSG, BPSGなどの基板は低い付着性を示している。また、付着エネルギー(ED)が0以下の値となった時に付着不良が急激に増加しており、予測どおりの結果が得られている事がわかる。下図(1)には、付着強度及び付着エネルギーの極性成分βS依存性を示した。図より、無機基板の極性成分が減少するにつれ、溶液中の付着力および付着エネルギーは増加する事がわかる。βS値が約6(dyn/cm)1/2以上になると付着エネルギーEDは負の値となり、これに伴い付着強度も低下する事がわかる。一方、下図(2)に示す様に、分散成分αsは付着エネルギーや付着強度に全く依存しない事がわかる。



以下の結果は、付着の挙動が表面エネルギーに支配されている事を示し、よって無機基板と現像液間の極性相互作用が高分子と基板間よりも強く生じたために起こっている。TMAH水溶液中での付着強度を向上させるには、基板の極性成分βSを低い値に設定する事が効果的であり、このMCPR2000H高分子膜の場合は少なくともβS<6(dyn/cm)1/2の条件を満足させる基板表面処理法が必要となる。具体的には、高分子膜をコーティングする前に基板を200℃以上でベークし、表面に吸着している極性要素(たとえば水分)を除去するデハイドべーク法などが挙げられる。右図は付着設計を行う際のβS値の最適化方法について示している。図には上述の乾燥下及び現像液中での付着強度のβS値依存性を同時に示している。これらは互いに逆の傾向を示している事がわかる。付着設計の際、たとえば乾燥下での付着強度(ドライエッチング時の付着など)を向上させる場合は、基板の極性成分を大きくし、逆に溶液中での付着強度(現像液中又はウェットエッチング中の付着強度など)を向上させる場合は極性成分を小さく、かつしきい値以下に設定させる。この様に基板の極性成分を各種表面処理法等によりコントロールすれば良い事がわかる。
以上のように、高分子と無機基板の付着現像は、基板の表面エネルギーの極性成分に大きく依存する。乾燥下での付着強化は基板の極性成分の増加に従って、増加の傾向を示すが、分散成分には殆んど依存性を示さない。又、逆にアルカリ水溶液中での付着強度は基板の極性成分が減少するに従い増加の傾向を示す。又、分散成分には同様に依存性を示さない。よって、乾燥下と溶液中の付着強度は、基板の極性成分に対し互いに逆の依存性を示す結果となった。この事より、高分子と無機基板との乾燥下、及び溶液中での付着メカニズムは、表面エネルギー理論すなわち各レーヤー間の極性相互作用が主要因となっている事がわかる。よって、付着力を向上させるには基板の極性成分を制御する事が効果的であると言える。
参考文献
- Akira Kawai, "Characteristics of Adhesion between Photoresist and Inorganic Substrate" Jpn. J. Appl. Phys. 28, 2137-2141 (1989).
ウェットエッチングと塗膜の内部応力
塗膜の内部応力は、代表的な界面の剥離要因である。界面付着性の向上には付着力を増大するよりも、内部応力の集中を回避することが効果的である場合が多い。ここでは、塗膜の内部応力の発生機構を実験的に検証することで、発生機構を理解する。また、有限要素法による応力分布解析を用いて、塗膜内の応力発生を考察する。具体的には、ライン、開口、方形等があり、これらの応力分布の点から考察した。熱応力分布は、2次元の有限要素法を用いて解析した。これらに基づき、塗膜の応力分布の制御手法を考察する。
塗膜には高分子材料を用いており、ノボラック樹脂を主成分としている。そして、Si(100)ウェハに成膜した酸化膜基板上に、スピンコート法で塗膜を形成した。その後、ホットプレート上で100℃、1分間のソフトベークを行い1.5μmの膜厚にした。様々な形状(ヌキ、残し、開口)を有したテストパターンを、塗膜内へ焼き付けた。その後、TMAH2.38%水溶液中に浸漬することにより現像し試験片として使用した。この試験片を、(ⅰ)ホットプレート上での高温(220℃)熱処理、(ⅱ)遠紫外線(DUV, 200~300nm)照射することで塗膜の熱応力発生を加速した。以上の試験片を50:1HF水溶液中へ5分間浸し、酸化膜基板層のエッチングを行なった。HF溶液中の付着強度を表す値として、塗膜膜下の酸化膜層のアンダーカット量を用いた。これは、光学顕微鏡による透過観察、あるいは電子顕微鏡(SEM)を用いた断面観察によって求める。下の左図にアンダーカット量の定義を模式的に示した。アンダーカット量Xは、酸化膜基板の界面方向のエッチング長さとして定義できる。塗膜として用いた高分子材料は可視光に対して透明であるため、アンダーカット量を光学顕微鏡で直接計測できる。下の右図には、実際の塗膜下に発生したアンダーカット形状を示している。


アンダーカット
塗膜内に応力が発生する原因として、(ⅰ)熱プロセスによる体積収縮、(ⅱ)基板との熱膨張係数の差が考えられる。高分子膜の場合、熱膨張係数の差によって生ずる応力が大きくなる。通常、この熱応力は下式で表す事ができる。
![]()
ここで、σ:熱応力、αr:高分子膜の熱膨張係数(1×10-4/℃)、αs:酸化膜基板の熱膨張係数(1×10-6/℃)、Er:高分子膜のヤング率(1Gpa)、Vr:高分子膜のポアソン比(0.33)、k:定数を示す。高分子膜を加熱し、次いで冷却する時にこの熱応力は発生する。ところが高分子膜の熱膨張係数は、酸化膜基板に比べ100倍大きいため、上式は以下のように書き直すことができる。
![]()
有限要素解析では、最初にテストパターン形状を三角形の要素に分割する。各要素の中で応力は等方的に生じ、フックの法則が成立することを前提として解析を行なう。ここで、有限要素解析を行なう上で、以下の仮定を行う。(1)フックの法則が成り立つ弾性領域を考える。(2)基板の熱収縮の影響は小さいものとする。(上式が成り立つ) (3)100℃の温度差を冷却した場合の熱応力を考える。解析の結果として、各要素の主応力の大きさと方向をベクトルで表示する。引っ張り応力を外向き、圧縮応力を内向きで表すものとする。また、凹凸部及び境界付近の分割要素を多くすることで、解析精度を向上できる。


(最大応力:引張り20MPa、圧縮20MPa)
上の左図に示す様に凹凸形状を1箇所ずつ有する平面パターンを考え、それを55個の三角要素に分割する。そして、有限要素解析の結果を上の右図に示す。凸部では引っ張り応力が、凹部では圧縮応力が集中している。各応力の最大値は、引っ張りが25MPa、圧縮が20MPaである。通常、高分子膜のクリープ現象は100MPaより現れるため、これらの応力は100℃温度差としては大きい値である。また、塗膜パターンのエッジライン近傍の応力増加が見られるが、離れるにつれ1/10以下に低下し等方的になる。すなわち、応力はパターン内部では外周形状の影響を受けず小さくなり、その逆も言える。下図は、遠紫外光を照射後に220℃でハードベークした場合の塗膜パターンのSEM写真を示している。この処理によって、応力発生をさらに加速できる。図のように、凸部では僅かながらの『そり』が、凹部では『しわ』を確認できる。この場合、凹凸部共にクリープ限界を超えている事がわかる。特に、凹部のしわは、塗膜が周囲からの圧縮変動に耐えられず、しわ状に変形したためである。よって、上の右図で示した応力分布に対応して、歪みが発生した事が確認できる。

下の左図には、これらのパターン部での発生したアンダーカット形状を示している。光学顕微鏡観察を用いて、HF水溶液への浸漬による酸化膜基板アンダーカット量が明確である。凸部でアンダーカット量は増加し、凹部ではかなり小さくなっている。ここ傾向は、凸部と凹部で発生する引っ張りと圧縮応力にそれぞれ対応している。下の右図には凹部と凸部での塗膜の変形モデルを示している。発生する応力は、塗膜/基板界面をせん断、および塗膜を基板から引き離す方向に働く。図(1)の凸部での引っ張り応力発生により塗膜の剥離が加速されるため、HF水溶液がしみ込みアンダーカット量が増加する。また、凹部では、全方向からの圧縮が生じるため体積が膨張し、エッチングが等方性になるため、下の左図のようにアンダーカット量は最小限になると考えられる。


下の左図に示す開口パターンは、半導体集積回路や表示デバイス回路によく用いる形状である。特に、高さの異なる平面内の信号配線を接続するコンタクトホールや、液晶層と配線層との位置を合わせるアライメントマークなどが代表的である。この開口形状によるHFエッチング形状は、開口部の内角でアンダーカット量が極端に少ない。これは、凹部に生じる圧縮応力の集中による影響である。また、一列に並んだ開口のうち、外側の開口のアンダーカット量が極端に増加している。開口パターンサイズにもアンダーカット量は影響される。そこで、開口形状を変化させてアンダーカット量を解析する。下の右図に示すように、開口寸法をa,b(パターンエッジに平行な方向をa)とし、開口端からパターンエッジまでの距離をcとした。


そして、その時のアンダーカット量をXとし、a,b,cの依存性を実験した。下の左図のように、エッジからの距離cが増加するにつれてアンダーカット量xも増加し、やがて飽和していく。また、寸法aに関しても同様な結果となっている。ところが、パターンエッジ面と垂直方向の開口寸法bには、まったく影響しない。下の右図のように、以上の結果をln(a・c)とXで表すと直線関係が得られるため、次式のようにアンダーカット量を表すことができる。
![]()



ここで、k1、k2は定数を表す。開口部に発生する応力は、開口端からパターンエッジまでの領域に存在する塗膜の熱収縮が原因で生じる。また、それはエッジと垂直方向の開口端での応力発生には寄与しない。エッジと開口端までの距離が極端に長くなると、右図のように、その間の塗膜の応力は小さくなり等方的に分布する。よって、上の左図におけるアンダーカット量の飽和を説明できる。アンダーカット量を制御するには、以上のパターン内の応力集中を考慮し、パターン形状を最適化する事が重要となる。
塗膜/基板界面に生じる応力分布とHF溶液中での付着挙動(アンダーカット)との相関を解析し、その有効性を確認した。凹凸パターン形状が応力集中を引き起こし、界面付着性に影響する。界面付着性コントロールに応力分布制御が有効であることを示した。
参考文献
- Akira Kawai, "Shrinkage Effect of Local Area of Polymer Film on Adhesion Behavior", Jpn. J. Appl. Phys. 33, L973-L974 (1994).
- Akira Kawai,"Adhesion of Micro Window Pattern Formed by Photolithography" J. Adhesion Society of Japan, 31, 360-362, (1995).
- 河合 晃、"レジスト微細パターン内の熱応力分布と接着特性" 日本接着学会誌、30, 549-554 (1994).
- Akira Kawai, "Dependency of Adhesion Behavior on Thermal Stress Distribution in Photoresist Micropatterns", Jpn. J. Appl. Phys. 32, 1020-1024 (1993).
塗膜の熱処理と溶液中の付着性コントロール

コーティング後の塗膜に対して、溶剤の乾燥および凝集力の増加を目的として熱処理を行う。また、各種溶液中への塗膜の浸漬処理も行われる。このような過酷なプロセス履歴により、塗膜の性質はコーティング直後から変化し、それぞれの適応性を備えて行く。ここでは、コーティング後の高分子膜に80~325℃の熱処理を行い、表面エネルギーモデルを用いて付着性の解析を行う。特に、溶液中および大気中での付着挙動の特性の違いに注目し、要因分析を考察する。熱処理に伴う高分子膜の表面および膜質変化について述べる。
ここで使用する高分子膜は、集積回路用の微細回路パターンのマスクとして重要なレジスト材料である。レジストには、Ag-Se系を利用した無機材料のものがあるが、取り扱いの容易さ、及び半導体表面に対する不活性さ等よりポリマーベースの有機レジストが主体となっている。ここでは、レジストの材料構造、及び光、熱に対する反応について概説する。レジスト材料は、バインダー樹脂、感光剤、溶剤の3つで構成されており、右図に示される様な化学構造をしている。(a)のバインダー樹脂は、m-,p-クレゾールホルムアルデヒドノボラック樹脂で構成され、メタ/パラ比(m/m+p)は約0.75である。重量平均分子量Mwも約20000近いものが多く、これは、現像液に対する溶解性、耐熱性に大きく影響を与える。また、(b)の感光剤は、エステル化率が約67%のトリヒドロキシべンゾフェノンであり、このエステル化率が現像液に対する溶解性に影響を与える。(c)はECA溶剤である。熱処理時には感光剤中のナフトキノンジアジド基がN2を脱離し、露光時と同様にケテンを生じる。そして、更にクレゾールノボラック樹脂との間でエステル結合を作り熱架橋していく。
水溶液中での付着実験として、下の左図に示すように、強アルカリであるTMAH2.38%水溶液中への浸漬テストを行った。基板材料として、Si(100)ウェハ上に1500Åの膜厚で形成したSiO2膜を用いた。SiO2膜表面の表面エネルギーが高いため、溶液中での接着不良を加速する事となる。スピンコート法により高分子膜をSiO2膜表面に1μmの膜厚で形成した。シランカップリング処理は行っていない。100μmの正方形パターンを高分子膜へ焼き付け、現像のためにTMAH2.38%水溶液へ浸漬した。現像後にホットプレート上で80~325℃の各温度で1分間の熱処理を行った。TMAH現像液中の高分子膜の付着強度として、パターン剥離が生じる浸漬時間を用いた。


上の右図(1)は、各熱処理温度における高分子膜の付着強度を示している。150~250℃の温度範囲で最大の付着強度を示している。高分子膜の最適な熱処理温度は、この範囲であると言える。ここでは、表面エネルギーモデルを用いて付着挙動を解析する。下の左図に、各熱処理温度における高分子膜の表面エネルギーと成分値を示す。表面エネルギーの分散成分γRdは全温度範囲で一定であるが、極性成分γRPは熱処理温度とともに増加している。表面エネルギーγRも極性成分γRPと同様な変化を示している。よって極性成分は分散成分に比べ、表面エネルギーの変化に寄与している。下の右図は、高分子膜とSiO2基板間の付着エネルギーを示している。ここで、WRLS,WRSは、それぞれTMAH水溶液中と乾燥下での付着エネルギーを表す。WIは、高分子膜/基板界面への溶液の浸透エネルギーを示す。付着エネルギーWは、付着仕事(mJ/m2)である。TMAH水溶液中での付着エネルギーWRLSは、250℃まで一定となるが、それ以上では減少する。これは、浸透エネルギーWIの増加がWRLSの減少の原因となり、WRSよりも密接に係わっている。250℃以上の温度では、付着エネルギーと上の左図の付着強度とは同様の傾向を示している。しかし、250℃以下の温度では付着挙動が説明できず、他の要因が支配的であると考えられる。




一般に、表面エネルギーを求める接触角法では、接触角の経時変化のない標準液を使用する。しかし、実際の付着実験に用いたTMAH水溶液は、高分子膜及びSiO2膜上で接触角の経時変化を示す。すなわち、高分子表面がTMAH水溶液中に浸漬している間に、何らかの相互作用が生じている。上の右図は、各熱処理温度における液滴の接触角変化を示す。エチレングリコールでは、滴下後15~180秒の範囲で接触角はほとんど変化していない。しかし、TMAH水溶液では、150℃以下と250℃以上の熱処理温度において接触角の経時変化が大きい。これらの温度領域で熱処理した高分子膜に対して、浸漬後の高分子膜の膜厚測定を行い膜質変化を評価した。上の左図はTMAH水溶液中へ浸漬した高分子膜の膜厚変化を示している。図(1)の付着挙動により、熱処理温度を(i)80~150℃,(ⅱ)150~250℃,(ⅲ)250~325℃に分けた。そして、各領域より80,175,300℃を選択した。80℃で熱処理した高分子膜の膜厚は、浸漬時間の増加に伴い減少するが、300℃の場合は増加する。また、175℃の場合はほとんど膜厚変化がない。すなわち、高分子膜の膜厚減少はTMAH水溶液中への溶解を意味し、膜厚増加は高分子膜の膨潤を示している。175℃の熱処理では、これらの反応が同時に生じたために膜厚変化が生じないと考えられる。よって、(ⅲ)250℃以上の熱処理後では、TMAH水溶液が高分子膜内へ浸透するために、上の左図の接触角の経時変化が説明できる。また、膨潤によって高分子膜の凝集性が著しく低下しているため付着不良の原因となる。次に、下図(a),(b)は高分子膜の溶解によるTMAH水溶液の表面エネルギーγLと付着エネルギーWの変化を示している。高分子膜の熱処理温度は80℃である。表面エネルギーγLは高分子膜の溶解とともに減少する。特に、極性成分γLPの減少が主要因となる。この事より、上の左図の150℃以下の熱処理温度での接触角の減少を説明できる。また、SiO2膜、及び高分子膜に対するTMAH水溶液の濡れエネルギーWLS,WLRも高分子膜の溶解量の増加とともに減少している。よって、この現象が浸透エネルギーWIを増加させる要因となり、TMAH水溶液中での接着エネルギーWRLSの減少を説明できる。よって、図(1)に示した(i)80~150℃の熱処理温度による高分子膜の付着性低下を説明できる。このように、水溶液中での高分子膜の付着メカニズムは、膨潤や溶解などの要因が関与する。これが大気中での付着性とは異なる点である。

以上のように、80~325℃の温度範囲で熱処理した高分子膜の水溶液中を解析した。TMAH水溶液中での付着挙動は150~250℃の温度範囲で最大値を示す。水溶液中と大気中で逆の特性を示すことは注目すべきである。これは、コーティング膜の耐久性の設計面からも、熱処理温度の設定が重要になることを示している。
参考文献
- Akira Kawai, "Adhesion of Photoresist Pattern Baked at 80 to 325℃ in Tetramethyl-ammonium- hydroxide Aqueous Solution", Jpn. J. Appl. Phys. 31, 3725-3730 (1992).
界面構造と付着性
通常、接着界面は接着基材によって覆われてしまうため、その様子を知ることが困難である。また、見かけの接着面積と実際の付着面積とは、一般的に異なることが多い。はたして、微細なスケールでの接着挙動はどのようになっているのであろうか。ここでは、このような接着界面におけるミクロな挙動に注目し、以下の4点について概説する。特に、粘性指状変形として、フラクタル的な接着面の変形挙動を紹介し、付着挙動との関係をについて述べる。
(1)2枚のスライドガラスで挟んだ高分子膜をベーク処理した場合、一般的に、フラクタル的な粘性指状のVF変形(VF: Viscous Fingering)が高分子膜内に生ずる。これは、ギャップ間で急激に溶剤がガス化したことが原因であり、高分子膜のベーク処理を急速に行うほどVF変形は顕著になる。また、VF変形度が高くなるにつれて、高分子膜とガラス間の接触面積は減少し接着強度は低下する。特に、Saffmanのモデルを用いて、高分子膜のVF現象を概説する。
(2)多層構造内の高分子膜を熱処理すると、高分子膜中に含まれる溶剤の蒸発によって粘性指状の微小空隙が多数形成される。本研究では、空隙形成に伴う高分子膜の応力緩和と応力集中に注目して、Glass/高分子膜/Cu/Al/Glass多層構造の破壊特性解析を行う。高分子膜によって張り合わされたGlass基板とCu/Al/Glass多層基板間の破壊強度を、引張り試験機を用いて測定し、高分子膜中の空隙面積の増加に伴い高分子膜の破壊強度が高くなることと、空隙周辺ではAl/Glass界面での剥離が生じることを示す。有限要素法による応力分布解析により、これらの現象の原因が、空隙形成に伴う高分子膜の内部応力緩和と、空隙周辺部での応力集中であることを述べる。
(3)高集積半導体デバイス(LSI)などの金属配線として多用されているCu/Al多層膜構造において、微細化に伴う強度改善が重要な課題となっている。特に、大気暴露したAl膜表面には自然酸化膜が容易に形成されるが、剥離試験の結果、この自然酸化膜層において破壊が生じている。また、自然酸化膜の存在により、Cu膜とAl膜とのミキシング層の形成が妨げられることを指摘する。このように、界面に存在する自然酸化膜は、多層膜構造の接着強度に大きく影響を及ぼすことについて概説する。
(4)基板の凹凸形状に依存して、接着膜の濡れ広がり方が影響を受けることを述べる。基板上に作製したミクロンサイズの正方形格子パターンの高さと周期を変えることにより, 基板上の液滴の平面形状は、八角形や正方形に変形する。また、平坦基板に対する表面積比rが約1.5以上になると、この液滴歪みが顕著になる。これは、各格子パターンが液滴の拡がりに対する抑制のポテンシャルとして働き、かつ、拡がり方向によって単位長さ当たりの格子パターン数が異なるためであることを概説する。
接着層や塗膜に含まれる溶剤の蒸発コントロールは、接着性の問題を扱う上で重要となる。一般的に、高分子膜内にガスが急速に発生した場合、Viscous Finger(VF)現象として知られるフラクタル的な粘性指状の変形が生じる。これは発生したガスによって、高分子膜自身の粘性変形が生じるためである。この高分子膜内でのガスの急速な発生は、高分子と基板との接着特性にも影響すると考えられる。このガスは高分子膜の溶剤、および熱分解による反応生成物である場合が多い。著者は、これまで高分子膜内の水溶液および溶剤の透過性について研究してきた。水溶液およびガスは、高分子膜中を比較的容易に透過する。また、基板上に形成された高分子膜内にガスが極端に急速に発生した場合は、高分子膜の局所的な剥離を生じさせるほど強い応力が生じる。一方、高分子膜として用いたフォトレジストは半導体集積回路(LSI)製造時のリソグラフィのマスク材料として、これまでに多く用いられてきている。その際、高分子パターンと金属や酸化物などの無機材料基板との接着の問題は重要となる。ここでは、高分子膜内に含まれる溶剤の蒸発に伴う粘性指状の変形(VF変形)を解析し、基板との接着挙動への影響を考察する。
この高分子膜はノボラック樹脂、感光剤、溶剤の3成分から成っている。ノボラック樹脂の熱軟化温度は約150℃である。感光剤はナフトキノンジアジドであり、分解温度は135℃である。溶剤はエチルセルソルブアセテートであり、沸点は156℃である。ガラス基板上に、高分子膜をスピンコート法で膜厚10μmに形成した。さらに、洗浄済みの他のスライドガラスと共に高分子膜を挟んで試料とした。高分子膜のベーク処理温度は80~300℃とした。ベーク処理のシーケンスとして、(ⅰ)急速ベークと(ⅱ)段階ベークの2種類を用いた。
高分子膜とガラス基板間の接着強度は、剥離試験機を用いて、高分子膜で接着された2枚のスライドガラスを分離させるときに要する力を測定する。高分子膜、およびスライドガラスの表面自由エネルギーγは接触角法で測定できる。また、次式を用いて接着エネルギーWaが求まる。
![]() (1)
(1)
ここで、r、gは、それぞれ高分子膜(レジスト)とガラスを表す。接触角測定の液滴には、純水、ヨウ化メチレン、エチレングリコールを用いた。また、高分子膜内の残留溶剤量は、熱天秤型重量計(TG)で測定できる。

(a)急速加熱,(b)段階加熱
上図(1)の(a)、(b)には、各ベーク処理法による高分子膜の表面観察像を示している。これらは、剥離試験後の高分子膜表面である。上図(1)の(a)の急速ベークの場合は、150℃のベーク処理でVF変形が明確に観察される。しかし、レジスト膜は200℃以上のベーク処理では細いしわ状にしか残っていない。そのため、ガラス基板との接触面積もかなり低減しているものと考えられる。一方、上図(1)の(b)の段階ベークの場合、150℃でのベーク処理ではVF変形は急速ベークの場合とほぼ同一である。しかし、300℃でベーク処理した場合でも、150℃のベーク処理と同程度の変形度を示している。ガラス基板との接触面積は、段階ベークした高分子膜の方が大きいと考えられる。このように、VF変形はレジスト膜のベーク処理シーケンスに大きく影響を受けることがわかる。これは、密閉された空間での高分子膜内の溶剤の蒸発に伴う局所的な圧力増加に大きく依存すると考えられる。

熱処理温度依存性

熱処理温度依存性
右の上図には、各ベーク処理における試料の接着強度を示している。両ベーク方法において、ベーク温度の上昇とともに接着強度が増加するのがわかる。また、段階ベークを行った場合の方が、急速ベークよりも接着強度は全温度範囲において高くなっている。このベーク方法による接着強度の差は、図(1)の高分子膜の形状の観察結果から、高分子膜とガラス間の接触面積の差が主な原因であると考えられる。右の下図に(1)式で求めた高分子膜/ガラス間の接着エネルギーWaと、TG測定による高分子膜内の溶剤残留量のベーク温度依存性を示している。ベーク温度の増加に伴い、高分子膜とガラス間の接着エネルギーWaは増加することがわかる。また、TG測定結果より、溶剤であるECAの沸点(156℃)あたりで高分子膜内の溶剤量が急激に減少するのがわかる。これらの結果より、高分子膜の熱重合に伴う表面自由エネルギーと凝集力の増加が考えられるため、右の上図のベーク処理温度上昇に伴う接着強度の増加が説明できる。
以上のように、段階ベーク処理をすることでガス化した溶剤が高分子膜中を徐々に発散させる事ができ、高分子膜内に局所的に圧力がかかることはないと考えられる。しかし、急速ベークを行った場合は、高分子膜内に発生したガスが高分子膜/ガラス界面に局所的に集中し、高分子膜を変形させる結果となる。このように、高分子膜と基板との接着性において、溶剤の蒸発コントロールが重要である。
VF現象に関する研究には、Saffmanらの基礎的な解析があるが、最近ではJacobらによって理論的に研究されている。一般的に、流体の変形はナビエ・ストークス方程式に基づいて解析されるが、その時のギャップ間の流体内の圧力Pは、ラプラス場(∇2P=0)として表される。そこで、流体内でのVFパターンの成長速度νは下式で表される。
ν = (-b2/ 12η ) ∇P (2)
ここで、bはギャップ間隔、ηは流体の粘性係数を表す。ここで、急速なベーク処理は高分子膜内での圧力勾配∇Pの増大を意味するため、成長速度νは大きくなりVFパターンの成長が顕著になることが考えられる。これは、図(1)にあるように、急速ベークのVFパターン成長が、段階ベークよりも顕著であることを説明している。一方、ベーク温度の上昇により、熱重合に伴う高分子膜の粘性係数ηの増加が考えられる。そして、成長速度νは減少しVFパターンの成長が遅くなると予想される。これは、300℃近くのベーク温度においてVFパターンの成長が殆ど見られないことから、粘性係数ηの増加が支配的であることがわかる。また、(2)式より、ガラス間のギャップ間隔bはVF成長速度に対して二乗で影響するため、試料の膜厚測定精度が重要であることもわかる。
一方、VFパターンの成長速度νとVFパターン先端の曲率半径ρとの間には、下式が成立する。
ν・ρ2 = 一定
この式より、急速ベークにおいては、成長速度νの急速な増加に伴い曲率半径ρは小さくなることが予想される。しかし、図(1)にあるように高分子膜は筋状にしか残っておらず、まるで曲率ρが増大したかのように観察される。しかし、実際には高分子膜内に発生したガス量が多かったため、高分子膜を殆どギャップ外へ押し出したことによると考えられる。
一方、VF現象において、曲率半径ρとギャップ間隔bの比は下式で表される。
ρ / b = ( Ca )-1/2
ここで、Caはキャピラリー数と呼ばれ、ギャップ間の流体の運動の特徴を表す無次元の値で表される。
Ca = ην / γ (3)
ここで、γは粘性液体と基板間の界面エネルギーである。図(1)の観察結果から、ρ≒0.1mmでb=10μmであるとすると、Ca≒0.01となる。ここで、Ca=0.3以下である場合は、流体の流れは粘性的であると考えられる。(0.3以上であれば、浸透性であると考えられる。) また、この場合、η=60cp、γ=40mJ/m2となり、Ca=0.01とすると(3)式よりVFパターンの成長速度νは約6.7×10-4m/sになることがわかる。これは、測定に用いた試料の一辺のサイズが5mm程度であるため、VF模様は約1分間のベーク処理によって試料全体に及ぶことが予想される。これは、図(1)に見られる実際の観察像(急速ベークの場合)を説明するものである。
VFモデルは、粘性流体において非圧縮性でストークス近似されている。しかし、実際にはベーク処理により高分子膜の凝集性が増加し、局所的な応力分布が生じると考えられる。よって、実際の接着強度を考察する上では、高分子膜内の応力分布とVF変形との相関をさらに検討する必要がある。
以上をまとめると、ここでは、ギャップ間にある高分子膜内に発生するVFパターンをSaffmanのモデルを用いて解析した。また、溶剤蒸発をコントロールする事で高分子層の接触面積低下を防ぎ、ガラス基板との接着力を増加できる。これらの結果は、溶剤を含む他の接着系においても適用できると考えられる。
一般に、接着層などにおける高分子材料における破壊現象は、応力特異点となる材料中の空隙や亀裂などの不連続点から主に生じると考えられている。 この点に関して、亀裂の先端周辺部での応力分布解析などが行われている。しかし、多数の空隙を有する接着層の破壊特性の評価には、亀裂形状や空隙近傍の応力分布だけではなく、空隙の大きさや空隙数などを考慮した接着層全体の応力分布解析が必要になる。また、現在、Cu/Al多層構造が半導体メモリなどの電子デバイス用の配線として実用化されている。 このCu/Al多層膜の加工には、通常、マスク材料であるノボラック樹脂を主成分とした高分子膜(レジスト膜)が塗布される。ここでは、Glass/高分子膜/Cu/Al/Glass多層基板を熱処理した際に、高分子膜内の溶剤蒸発によって微小空隙が形成されることを見い出し、粘性指状(VF: Viscous Fingering)変形理論に基づいて解析している。ここで、VF変形とは、粘性膜中に気体が発生した場合、気泡の成長に伴う粘性膜の局所変形として定義する。また、VF変形は、手の指の形状に似たフラクタル的な変形をする。この現象は、グリセリン中での気泡成長をモデルとして、詳細に解析されている。そこで、ここでは、Glass/高分子膜/Cu/Al/Glass多層基板において、高分子膜中の多数の空隙が破壊強度に与える影響について注目する。特に、破壊強度の空隙面積依存性を測定するとともに、空隙形成に伴う高分子膜全体の応力分布変化の影響について、有限要素法を用いて考察する。
Glass基板の寸法は、縦15mm、横15mm、厚さ1.0~1.2mmである。洗浄後のGlass基板に、真空中でAl膜に続いてCu膜を連続して積層した。膜厚はAl膜が500nm,Cu膜が15nmであった。Cu/Al/Glass多層基板の表面粗さを、原子間力顕微鏡(Atomic Force Microscope,以下AFM) により測定し、二乗平均粗さRmsが9~12 nmの範囲にある膜を選んで試料とした。次に、Cu/Al/Glass多層基板上に、高分子膜をスピンコート法によって膜厚10μmに塗布した。この高分子膜を接着層として、別のGlass基板(縦5mm、横5mm、厚さ1.0~1.2mm)を重ねて接着した。ここで、Glass基板を接着する前に、溶剤を蒸発させる処置はしていない。接着層として使用した高分子膜(レジスト)は、m,p-クレゾールノボラック樹脂,感光剤,溶剤の3成分からなっている。m,p-クレゾールノボラック樹脂の熱軟化温度は150℃,感光剤であるナフトキノンジアジドの熱分解温度は135℃,溶剤であるエチルソルセルブアセテートの沸点は156℃である。熱処理時の到達温度は150,200,250,300℃と変化させた。高分子膜は150℃以上の熱処理により、感光剤は殆ど熱分解すると考えられる。下図に作製した試料断面の模式図を示す。

引っ張り試験機を用いて、上図のように、試料に引っ張り力(最大156N)を加えて破壊させ、破壊の際に要した引っ張り力を試料の破壊強度F(N)とした。さらに、試料の破壊面の実効接触面積S(m2)を要素分割法により測定した。ここでの実効接触面積とは、Glass基板全体の面積から、接着に寄与しない空隙の面積を差し引いた面積であるとして定義した。
一般に、高分子膜を熱処理すると、内部応力が発生する。今回、高分子膜内の空隙発生と内部応力との関係を解析するために、2次元有限要素法により高分子膜の内部応力分布を求めた。ここで、熱応力σ(Pa)は一般的に下式で表すことができる。


ここで、高分子膜の熱膨張係数αrは1×10-6 /℃,高分子膜のヤング率Erは1GPa,高分子膜のポアソン比nrは0.33とした。また、近似として、基板の熱変形は高分子膜に比べて少ないとしたため、熱膨張係数αsは考慮していない。解析に用いた要素分割モデルを右図に示した。解析領域は1mm2であり、高分子膜の膜厚は10μmである。これを392の三角要素に分割した。右図中の●は、熱収縮が生じても変形しない固定点を表す。固定点を試料の周囲だけに限定した理由は、以下の通りである。すなわち、熱処理中は、溶剤が残っているため、高分子膜/Cu界面は常に流動的である。また、顕微鏡による観察の結果、熱処理中では、空隙形状は常に変化している。よって、もし、界面全体を固定点とすると、空隙の形状変化ができなくなり、現実の系から離れることになる。
以上の条件を用いて、高分子膜に150℃の温度変化(冷却時)を与えた際に生じる内部応力を解析した。
高分子膜の表面エネルギーは、接触角法で求めた。表面エネルギーの既知である液体を高分子膜上に滴下して、1分経過後の接触角を測定した。各液の接触角および成分値を用いて、下式により高分子膜の分散成分γRd、極性成分γRpを求めて、表面エネルギーγR(=γRd+γRp)を算出した。
γL ( 1 + cosθL ) = 2 ( γRd・γLd )1/2 + 2 (γRp・γLp )1/2
ここでγLは液滴の表面自由エネルギー、γLdおよびγLpはそれぞれ分散および極性成分を表す。θLは高分子膜上での接触角を表す。接触角測定用の液体として、ヨウ化メチレン(γL/γLd/γLp = 50.8/46.8/4.00 mJ/m2)、および純水(γL/γLd/γLp = 72.8/291./43.7 mJ/m2)を用いた。
引張り試験機で破壊した試料の破壊面の顕微鏡写真を下の左図(2)に示す。この試料には、300℃の熱処理が施されており、破壊強度は145Nであった。下の左図(2)に示すように破壊面は、①空隙,②Al/Glass界面破壊,③高分子膜/Cu界面破壊の3種類の領域に大別できる。ここで、空隙はVF現象として知られるフラクタル的な粘性指状の形状をなしている。また、このような空隙の形状は、高分子膜中の溶剤の急激なガス化によって形成されることを、河合研究室では既に報告している。一方、空隙以外の領域である②,③は、Cu/Al/Glass多層基板とGlass基板が、高分子膜によって接着されていた領域である。この領域の大部分では、高分子膜/Cu界面破壊③が生じているが、空隙周辺部では、Al/Glass界面での破壊②も生じている。


熱処理温度依存性
次に、高分子膜の熱処理温度に対する破壊強度F(N)、及び実効接触面積S(m2)の関係を上の右図(3)に示す。試料の熱処理温度が150℃から300℃へ増加するのに伴い、300℃の接着層の実効接触面積Sが150℃の試料の約2/3にまで減少している。この面積減少の原因は、熱処理温度の上昇に伴う高分子膜内の空隙面積の増加である。ここで、上の右図(3)中の測定点aは、上の左図(2)に示した試料の破壊強度を示している。ここで、測定で得られる試料の破壊強度F(N)を、下式のように接着層の単位面積あたりの破壊強度T(N/m2)と実効接触面積S(m2)の積として定義する。
破壊強度 F(N) = 単位面積あたりの破壊強度 T(N/m2) × 実効接触面積 S(m2)
一般には、試料の破壊強度Fは、実効接触面積Sの減少に伴って減少する。しかし、上の図(3)に示すように、熱処理温度が150℃から300℃に増加することによって、実効接触面積Sが約2/3にまで減少したにもかかわらず、逆に破壊強度Fは約2.7倍に増加したことが分かる。これは、単位面積当たりの接着層の破壊強度Tが増加したためであると考えられる。ここで、単位面積当たりの破壊強度Tの増加要因の1つとして、熱処理に伴う高分子膜の表面エネルギーγの増加と、それに起因するCu膜との接着仕事の増加が考えられる。この理由として、図(2)の破断面では、高分子膜/Cu界面での剥離の占める割合が高いためである。また、高分子膜のヤング率や硬度、Tgなどの影響が全くないとは言えない。しかし、高分子膜の凝集破壊は殆ど生じていないことから、表面エネルギーを主要因とした考察が妥当であると考える。よって、150℃から300℃への熱処理温度の増加に伴う破壊強度Fの挙動を、高分子膜の表面エネルギー変化の点から考察する。まず、高分子膜の表面エネルギーγ、および、その成分(極性γp,分散γd)の熱処理温度依存性を下図に示している。高分子膜の表面エネルギーの分散成分γdは、熱処理温度を変化させてもほとんど変化しない。一方、極性成分γpは100~200℃の範囲では一定だが、250~300℃の範囲では熱処理温度の増加に伴って増加している。特に、熱処理温度が300℃の試料では、150℃の試料に対して極性成分γpが約2倍になっている。この極性成分γpの増加が原因となり、熱処理温度300℃の試料の表面エネルギーγは、150℃の試料に対して約1.2倍に増加していることが分かる。その結果、この表面エネルギーの増加に伴ってレジスト/Cu界面の接着仕事が増加すると考えられる。しかし、上述のように、高分子膜の表面エネルギーγの増加は1.2倍程度であるので、図(3)に示した試料の破壊強度Fの増加分(約2.7倍)を説明することはできない。よって、表面エネルギーの増加の他に、さらに大きく破壊強度Fを増加させる要因があると考えられる。

そこで、有限要素法を用いて、多数の空隙を伴った高分子膜の内部応力分布を解析する。下図には、内部応力分布の解析結果を示す。まず、下図(a)に示したモデルは、空隙を持たない高分子膜である。膜全体に100 MPa程度の大きな応力(引張り)が、均一に分布していることが分かる。次に、下図(b) と(c)に示したモデルは、それぞれ3個と8個の空隙を有した高分子膜を示している。その結果、空隙数の増加に伴って接着層の実効接触面積が小さくなるが、空隙以外の高分子膜部の内部応力も徐々に低くなることが分かる。よって、この高分子膜の内部応力緩和が、図(3)で示した実効接触面積の減少に伴う破壊強度増加の主要因であると考えられる。また、空隙を有する下図(b)と(c)のモデルでは、空隙の発生に伴って局所的に応力分布が不均一になっているのが分かる。特に、空隙周辺部において、応力が集中している。この応力が集中している空隙周辺部では、図(2)に示したようにAl/Glass界面で破壊が生じている。したがって、Al/Glass界面破壊は、この空隙周辺の応力集中によって生じたものであると考えられる。この様に、有限要素法による応力分布解析によって、空隙形成を伴う接着層の破壊挙動を、定性的に解析することが可能になる。

(a)ボイドなし, (b)ボイド3個, (c)ボイド8個
ここでは、多数の空隙形成に伴うレジスト膜の応力緩和と応力集中に注目して、Glass/高分子膜/Cu/Al/Glass多層基板の破壊特性解析について述べた。そして、以下の点について概説した。
・多層基板の破壊強度の増加は、空隙の発生に伴う高分子膜の内部応力緩和と表面エネルギー増加が主な原因となっている。
・下層のAl/Glass界面剥離が生じる原因は、高分子膜中の空隙周辺部における応力集中である。
以上のように、多層構造を有する試料において、高分子膜中の空隙形成に伴う破壊強度の増大メカニズムを明らかにした。次に、Al膜表面に形成される自然酸化膜の影響について考察する。近年、半導体集積回路の配線材料として、Cu-Al多層膜およびCu単層膜が多く用いられている。これは、エレクトロマイグレーションやストレスマイグレーションが原因で生じる断線を防ぐためである。また、Al配線の加工時には、Al膜表面に数10nmの膜厚の金属膜(主にCu、Tiなど)を堆積させて、表面反射率を下げることが行われる。これは、光リソグラフィ時にAl膜から反射光によって、高分子マスク形状が劣化するのを防ぐためである。このように、Al系多層膜構造はその機能性と安定性の高さのために、今後も重要度が増すと考えられる。しかし、多層膜界面での弱結合層の形成、あるいは応力のミスマッチよる構造破壊などの数々の不安定要因も多く含んでいる。一般に、Al膜表面は酸化反応の標準自由エネルギーが低いため、大気中でも数ナノメーターの酸化膜層を容易に形成する。ここでは、Al膜上に形成された自然酸化膜がCu/Al多層膜構造の破壊強度に及ぼす影響について注目し、そのメカニズムを概説する。
スライドガラス上に、Al膜を500nmの膜厚で形成した。破壊強度に及ぼすAl膜の表面酸化層の影響を調べるために、次の2種類の多層構造試料を作製した。
Ⅰ : (大気暴露) Al膜の堆積後、一度試料を大気中(20℃、50%)で3日間保管することで自然酸化膜を形成させる。次いで、同様な真空蒸着法でCu膜(純度99.9%)をAl膜の上に15nmの膜厚で堆積させた。
Ⅱ : (連続成膜) Al膜の堆積後、同一の真空内で引き続きCu膜を15nmの膜厚に堆積させた。
作製した多層基板上に、高分子膜をスピンコート法(1000rpm、30s)で膜厚約3μmに形成し、さらに、もう一枚の同様な多層膜基板と共に高分子膜を挟んで試料とした。高分子膜の主成分はノボラック樹脂、感光剤(ナフトキノンジアジド)、溶剤の3成分から成っている。ノボラック樹脂の熱軟化温度は約150℃である。溶剤はエチルセルソルブアセテートであり、沸点は156℃である。多層膜の破壊強度は、剥離試験機を用いて行い、高分子膜で接着された同一構造の2枚の多層膜基板を分離させるのに要した負荷を破壊強度とした。
接触角法により大気暴露後のAl膜表面の純水接触角を測定し、大気暴露時間に伴うAl膜表面の濡れ性変化をモニターした。また、Auger電子分光法により、Cu/Al多層膜の深さ方向の元素分布を測定し、自然酸化膜および界面ミキシング層を解析した。また、EPMAを用いて破壊試験後の試料表面の元素分析を行い、破壊層の同定を行った。歪みゲージを用いて、高分子膜、Al膜およびCu膜の応力を測定した。

大気暴露後の時間依存性
右図はAl膜表面の純水の濡れエネルギーと接触角の大気暴露後の放置時間依存性を示したものである。接触角は徐々に増大し、数日かけて表面層が形成されていく様子が現れている。この表面層は後述のようにAuger電子分光法による元素解析により酸化膜であることを確認した。Williamsらは、Si単結晶表面では室温中での2nmの自然酸化膜成長に伴い、接触角は37~72度まで変化することを示している。また、通常、この成長が平衡状態に達するには2~3日を要する。右図において、10分間経過以降の濡れのエネルギー変化は、下式で表されるような鮫島らの提案による吸着現象に相当することが分かる。
v = k・lnt + B
ここで、vは吸着により変化する物理量(ここでは、濡れのエネルギー)、tは経過時間、Bは定数、kはグラフの傾き(=-6.5)を表す。また、25℃におけるAlの酸化反応の標準自由エネルギーは約(-251kcal)であり、これはCu膜(-70kcal)よりも低い値である。よって、多層膜構造にした場合、熱力学的には、Al膜表面の自然酸化膜中の酸素原子はCu膜中へ移動する可能性はない。


右図(a)、(b)はAuger電子分光法で解析したCu/Al多層膜の深さ方向の元素分布を示している。Ar+イオンによるエッチングによって、両方の試料とも表面から約40nmの深さまで解析している。右図(a)の大気暴露した試料は、Cu-Al膜界面において酸素原子のピークが高く、自然酸化膜が安定して存在していることが分かる。しかしながら、右図(b)の連続成膜で作製した試料の場合、Cu-Al界面での酸素濃度は低いがCu原子濃度が比較的高くなっているのが分かる。すなわち、界面においてCu-Al系のミキシング層が形成されたと考えることができる。また、大気暴露構造のように界面に形成された自然酸化膜は、ミキシングを抑制するバリアとして働くことも分かる。また、Al膜表面に形成された自然酸化膜層は非常に脆く、弱結合層として働くことを以前報告している。右表には、歪みゲージで測定した高分子膜、Cu膜、Al膜の全応力(応力×膜厚)を示している。Cu膜の全応力は、高分子膜とAl膜の両方の値に対して大きく異なっている。よって、多層膜構造における応力集中は、高分子膜-Cu膜間とCu膜-Al膜間の両側の界面で生じると考えられる。最終的には、付着力の弱い界面で破壊が生じると考えられるが、この結果は、多層膜構造の破壊特性にも大きく影響すると考えられる。下の左図(a)、(b)には、破壊試験後の試料表面の光学顕微鏡写真と破壊強度を示している。二つの写真からは破壊面構造には大きい差は見られないが、大気暴露した多層膜構造の破壊強度は、連続成膜構造に比べて約1桁低くなることが分かる。そこで下の左図(a)大気暴露した膜の破壊面をEPMAで元素分析(線分析)した結果を下の右図に示している。これにより、局所的にCu膜が無くなり剥離しているのが分かる。この様に、ミクロな領域でのCu膜の破壊は大気暴露膜の場合に多く生じているのが分かる。すなわち、大気暴露の場合には, Al膜表面に自然酸化膜が生じていたためにミキシング層が十分に形成されず、Cu膜とAl膜との界面の接着力は比較的弱くなったものと考えられる。この結果は、右表の応力解析結果のように、Cu膜-Al膜間の応力差が大きいことからも説明できる。また、このCu-Al膜界面での剥離は、破壊面内に多く見られることから、全体の破壊強度を支配しているものと考えられる。一方、下の左図(b)の連続成膜の場合は、Al膜がガラス基板から剥離する領域が確認できる。(図中丸印)これは、ミキシング層がCu膜とAl膜との界面に存在するため界面強度は高くなったためであると考えられる。よって、連続成膜による多層膜構造の破壊強度が高くなったものと考えられる。


このように、Cu-Al界面における自然酸化膜層の存在により、多層膜構造の破壊特性が大きく変わることが明確になった。今後、電子デバイスの配線材料としての重要度を増していく多層構造において、自然酸化膜などの極表面層にまで精密な制御が必要とされる。
Cu-Al多層配線構造の破壊強度について、Al膜表面に形成される自然酸化膜の影響に注目して解析してきた。自然酸化膜の存在により、Cu膜とAl膜界面にはミキシング層は形跡されず、多層膜構造の強度を低下させる。
参考文献
- P.G.Saffman and G.I.Taylor, Proc. Roy. Soc. A245 312 (1958).
- 宮島佐介訳, フラクタル成長現象, p1 朝倉書店.
- A.Kawai, Jpn. J.Appl.Phys.30 121 (1991).
- 河合 晃, 日本接着学会誌, 31 187 (1995).
熱処理によって大気中の付着力は増加する

塗膜の基板材料には、電子デバイス材料であるSiO2、BPSG、Si3N4、Al、Siの各膜を用いた。SiO2膜は熱酸化法で、Al膜はスパッタリング、BPSG膜とSi3N4膜はCVD法を用いて形成した。右図には付着テスト用の試験片の構造断面図を示している。2枚の正方形の基板(5mm×5mm)で高分子膜を挟んだ試験片を作成した。この試験片を80~325℃の各温度で5分間ホットプレート上で熱処理を行った。HMDSの様なシランカップリング処理は行っていない。密着力試験機を用いて試験片に剥離荷重を加えた。この時の剥離荷重は1~20kg/cm2であり、実験は25℃にて行った。この試験片が分離される荷重を付着強度とした。接触角計を用いて各高分子膜の表面エネルギーを求め、それより付着エネルギーを計算した。ここでは、分散、極性成分に加え、水素結合成分も考慮した。また、エリプソメーターを用いてλ=633nmでの高分子膜の屈折率を測定した。


熱処理温度依存性
種々の無機基板と高分子膜間の付着強度の熱処理温度依存性を上の左図に示す。付着強度は150℃までは僅かに減少し、200℃を超えると急激に増加する。本実験で用いた試験片の全てが同じ傾向を示し、150~200℃の温度範囲で付着強度の最小を示している。これは、水溶液中での付着挙動と逆の特性である。SiO2基板では比較的大きい付着力を示すが、Al膜表面では付着強度は小さい。電子デバイス製造に実用的な付着強度を得るには、高分子膜を約250℃以上で熱処理する事が必要である。ここで、表面エネルギー理論を用いて付着挙動を解析する。上の右図には高分子膜の各熱処理温度における3成分(分散、極性、水素結合)値の変化を示している。高分子膜の表面エネルギーγRは、200℃までは僅かに減少し、200℃以上で急激に増加する。このγRの熱処理温度依存性は、上の左図の付着挙動と似ている。高分子膜の分散成分γRdと極性成分γRpは各々31mJ/m2, 2.5 mJ/m2でほぼ一定である。分散成分は表面エネルギーの3成分のうち一番大きい値を示すが、表面エネルギーの変動には寄与していない。しかし、水素結合成分は高分子膜の表面エネルギー変化の原因となっている。下の左図には、表面エネルギーより求まる付着エネルギーWの熱処理温度依存性を示している。付着エネルギーは200℃までは僅かに減少し、200℃以上では急激に増加する。これは上の右図の表面エネルギーの挙動と同じである。分散力の相互作用Wdと極性力の相互作用WPは全温度範囲において、各々53, 15mJ/m2で一定となる。水素結合力による相互作用Whのみが付着エネルギーWと同様な変化を示し、付着特性の主要因となっている。下の右図は、各熱処理温度での高分子膜と各無機基板との付着エネルギーと付着強度との相関を示している。これらには正の相関が明確に見られており、表面エネルギー理論で付着挙動を説明できる。また、付着強度が0 kg/m2の場合の付着エネルギーは約70mJ/m2であるが、実際の付着性に寄与していない。そこで、付着エネルギーの各成分(Wd,Wp,Wh)と付着強度との関係を考察する。



右図(a)~(c)には付着エネルギーの3成分と付着強度の相関を示している。図より付着エネルギーは、分散力及び極性力による相互作用に対して相関を持たず、水素結合成分と密接な関係を示す。よって、この実験において、分散力と極性力による相互作用は、実際の付着強度の変化に寄与していない。上の右図における70 mJ/m2の付着エネルギーは、この2つの相互作用によるエネルギー量である。これらは、高分子膜が固体として存在するための凝集力に寄与しており、試験片における高分子膜の凝集破壊を阻止するための凝集エネルギーである。ここで、熱処理に伴う高分子膜の膜質変化を考察する。下の左図は高分子膜の密度と屈折率の熱処理温度依存性を示している。密度は、熱処理温度の上昇に伴い増加している。また、屈折率は200℃までは徐々に増加し、200℃を超えると急激に増加している。この屈折率の変化は高分子膜の組成、及び構造変化を敏感に表す。高分子膜の密度の増加により、高分子膜表面の-OH基密度も増加し、水素結合成分が相互作用の主流となることで、200℃以上での付着強度の増加が説明できる。次に、80~150℃の熱処理温度における付着挙動を解析する。下の右図は、高分子膜内の残留溶媒量と純水の接触角、及び屈折率の変化を示している。残留溶媒のみの影響を調べるため、感光剤の分解のない90℃で真空処理を行った。残留溶媒量を真空処理によって制御し、高分子固形分との重量比を示している。乾燥に伴って残留溶媒量が低下するに従い、接触角θ 及び屈折率は徐々に増加している。接触角の増加は高分子膜の表面エネルギーの減少を意味している。よって、高分子膜を80~150℃の温度で熱処理した時の付着強度低下の要因の一つとして、溶媒の蒸発が考えられる。


屈折率との相関
以上のように、大気中での付着強度は150~200℃の温度範囲で最小値を示す。水溶液中と大気中で逆の特性を示すことは注目すべきである。これは、コーティング膜の耐久性の設計面からも、熱処理温度の設定が重要になることを示している。
参考文献
- Akira Kawai, "Adhesion of Photoresist Pattern Baked at 80 to 325℃ to Inorganic Solid Surface", Jpn. J. Appl. Phys. 33, L146-L148 (1994).
はんだバンプの高精度剥離法とは(角度可変型剥離法)
LSIなどの電子デバイスの高集積化と高機能化に伴い、入出力端子数も増加し、半導体パッケージの入出力端子設計もそれに追従する必要が生じてきた。初期のDIP(Dual Inline Package)から多ピン化を追求したパッケージがPGA(Pin Grid Array)であり、また、薄型化を追求したパッケージがSOP(Small Outline Package)である。さらに、現在では1つのパッケージ内に3次元構造的にICやLSIおよび演算素子を積層するSIP(System In Package)が主流となっている。

上図にはSIPの概略図を示している。SIPでは、1つのパッケージ内に、3次元構造的にICやLSIおよび演算素子を積層することができる。さらには、多ピン化と薄型化を追求したパッケージとしてBGA(Ball Grid Array)が採用されている。BGAは、はんだバンプ電極として用いられるため、格子上に配列した構造になっている。はんだバンプの間隔(ピッチ)は、作製時にクリームはんだの量を調整することでファインピッチ化が可能である。現在は、主に直径約数100μmのはんだバンプが用途別に用いられているが、直径100μm以下のはんだバンプも主流になりつつある。ここでは、今後の5G世代のプリント基板技術として必須となる鉛フリーはんだ材料の接合技術と接着機構の評価方法について述べる。特に、2006年よりPb全廃の流れにより登場したSn-Ag-Cu系の鉛フリーはんだ材料に注目する。

半導体パッケージは、電子デバイスとしての動作信頼性を長期に保証するための基盤技術である。そのため、多くの技術のレベルアップが常に行われており、日々技術革新レベルの高い技術分野である。上図には、X線CTを用いて解析した半導体パッケージの3次元構造である。半導体チップ内の配線やBGAおよびプリント基板構造が非破壊で確認できる。また、ワイヤーボンディングの配線異常の有無なども確認することが可能である。BGAは半導体チップとプリント基板電極との接続部であるため、電気抵抗の制御はもちろんのこと、応力歪みや振動負荷などによる耐性を有している必要がある。下の図は、はんだバンプ構造の模式図である。BGA球の直下には、数層の金属層が形成されており、接続部への熱歪みや振動負荷を緩和させるバッファー層の役割を担っている。通常、金属層にはTi膜やMo膜などの積層膜を用いる。格子状に形成されたBGAはんだバンプは、リフロー法および熱圧着法などで半導体チップに接合される。その際、はんだバンプと電極(land)との界面に合金層が生成されることで、接合界面の機械的強度が増加する。しかし、リフロー条件により、合金層の構造が変化し、接合面の粗さおよび汚染などの影響も受けやすくなる。


RoHS指令とは、2006年7月にEU加盟国で施行された鉛全廃協定であり、全世界で鉛フリー化の流れが本格化した。それまで、プリント基板で主流としていた共晶鉛はんだ材料も撤廃の動きとなり、現在では新規はんだ材料は全て鉛フリーはんだ材料である。鉛フリーはんだの主流は、Sn-Ag-Cu系であり、多くの材料シリーズが実用化されている。鉛フリー化による大きい変革は、第一に高融点化である。右図には各種はんだ材料の融点を示している。従来のPb-63Sn共晶はんだの融点は183℃であったが、Sn-Ag-Cu系の鉛フリーはんだの融点は217℃となり、ほとんどの系で200℃を超えている。はんだ実装工程はパッケージ製品の最終工程になるため、それまで作製された全工程の材料や素子構造が200℃以上の熱処理を受けることとなり、プロセス条件や耐久性などの最適化を見直す必要が生じた経緯がある。それでも、Pbフリー化は地球上の環境問題として最優先であったことから、躊躇なく推進されてきた。下の2つの表には、従来のPb-63Sn共晶はんだとSn-Ag-Cu系の鉛フリーはんだの特性比較を示している1)-5)。ほとんどの機械的特性やエレクトロマイグレーション特性において、Sn-Ag-Cu系の鉛フリーはんだ材料が優れている。


半導体パッケージの信頼性評価の中で、はんだバンプの接合性評価は中核を占める重要な試験である。接合性評価は非破壊評価と破壊評価とがあり、一般的に電子工業では生産工程後、目視検査および電気的評価(導通試験)が行われている。はんだバンプの接着強度試験においては、直接剥離および破壊させて接合性を評価している。

上図には、一般的なはんだバンプの接合強度評価法を示している。従来より、シェアモード法、プルモード法、溶融モード法が主な試験方法として採用されてきた。シェアモード法は、シェアツールをはんだバンプに対してせん断方向に走査させて剥離する手法である。この手法は、実際の接合不良モードに近い試験法であると認識されている。プルモード法は、アームによってはんだバンプを機械的に挟み、上方向へ引張ることで剥離させる手法である。しかし、はんだバンプ直径が100μm以下になると、縮小化に適応したアームを作成することが困難になってくる。溶融モード法は、加熱したロッドをはんだバンプの頂点付近に接触させて溶融接合させた後、上方向に引張る手法である。しかし、縮小化したはんだバンプでは頂点付近のみを溶融接合させることが困難になり、バンプサイズの縮小化に適さない。よって、はんだバンプの縮小化の観点からは、シェアモード法を基本として、ツールサイズを縮小する方向性が有利である。このように、現実的に多くの試験方法が存在するため、各手法による接合強度の相関性が不明確になっている。さらには、熱歪み評価の観点からは、温度サイクル試験も実施されるが、この場合は1個のはんだバンプ試験ではなく、半導体チップを支えるはんだバンプ全体での熱疲労試験が必要となる。

上図はプリント基板上に作成されたはんだバンプの写真を示している。はんだバンプは、リソグラフィ技術により電極基板上にクリームはんだを局所的に形成し、その後、融点まで加熱することで表面張力により球形に成形する。クリームはんだの体積を一定にしておけば、球形のはんだ体積もほぼ同一に仕上がる。また、はんだ材料が溶融する際に、含有フラックスが気化し、バンプ内にボイド(空隙)を形成することが問題となっている。はんだバンプと電極界面にボイドが形成されると、本来の目的である電気伝導に支障が生じて信頼性試験にも影響する。そして、はんだバンプ形成後は、シェアツールを用いて、基板電極上での接合強度を測定する。ここでは、鉛フリーはんだとして代表的な鉛フリーはんだSn-3.0Ag-0.5Cuと従来の共晶はんだPb-63Snを対象として、接合強度の評価を行う。これらの組成は、下図に示すように、平衡状態図における共晶点となり、融点が最も低くなる特徴を有している。図中Q点は、Sn-3.0Ag-0.5CuとPb-63Snの各はんだ材料において共晶点の組成を示している。共晶形の平衡状態図の場合、単独素材(組成0%および100%)の融点は高いが、合金化することにより融点は低下する。その最小温度となる組成が共晶点である。

下の2つの図は、接合評価に用いるSn-Ag-Cu系鉛フリーはんだとPb-63Sn共晶はんだの断面における組成分布を示している。バンプ内部にはクラックやボイドは発生しておらず、均質な合金状態となっている。合金の溶融状態から共晶点での固化過程において、多数の微小な固溶体が点在している。この固溶体組織は、歪みの起点になる可能性があり、強度設計上では注意が必要となる。


下図は接合試験に使用したシェアツールの写真である。先端はシャープな形状となり、1個のBGAよりも長い幅を有している。ツール先端は基板に接触させずに、水平に移動させる。シェア試験においては、①水平移動のシェアモードと②角度シェアモードの2種類において試験を行った。シェアツールの移動はそのままで、基板の設置角度を水平(θ=0度)から角度(θ=30度)に設定して行う。よって、角度シェアにおいては、はんだバンプを引き上げる方向に応力が発生することになる。この基板に垂直に働く応力が理想的な接合評価法の機構となる。

下の図は水平移動のシェア剥離試験の剥離過程を示している。剥離試験時にシェアツールが基板と接触した場合、摩擦力が余分に生じるため正確な付着力測定ができなくなる。そのため、通常は荷重点をはんだバンプの底部ではなく、少し浮かしたポイントへ加える。図中、シェアツールが水平移動し、はんだバンプの中腹の高さで食い込んでおり、そのまま剥離は生じずに変形している。その後、限界を超えるとはんだバンプが電極界面から剥離する様子が見られる。この場合の剥離面には、はんだバンプの凝集破壊の痕跡が白濁した領域として確認できる。通常、水平シェアの剥離モードにおいては、はんだバンプの凝集破壊が生じるため、真の付着力計測が困難になる点が問題となっている。

その解決方法として、下の図は角度シェア法による剥離試験の剥離過程を示している6,7)。試験基板に傾斜を持たせてシェアツールを移動させる方法である。試験の初期段階でシェアツールは僅かにはんだバンプ内へ食い込むが、その後、界面からはんだバンプの剥離が生じる。これは、傾斜を付けたことにより、はんだバンプを基板から上方向へ引き抜く応力が働いたためである。剥離面においても、はんだ材料の残渣は僅かであり、理想的な界面剥離を実現できている。この手法がはんだバンプの真の付着力に近い試験法であると考えられる。通常、試験の傾斜角は30~45度あたりに最適点が存在するが、個々のケースにおいて若干最適化する必要がある。


右図は各剥離試験モードにおける剥離曲線を示している。水平シェアモードの場合は、初期の過程で局所的に界面剥離が生じ、その後、はんだバンプの変形が生じ、最終的に接合が破断する。また、剥離荷重の最大値は、初期の界面剥離後に生じている。はく離曲線の面積は、剥離仕事に相当するため、はく離仕事の大部分がはんだバンプの変形に費やされていることになる。一方、角度シェア剥離の場合は、剥離荷重の最大値で界面破壊が生じており、理想的なはく離曲線を描いている。このことからも、角度シェアモードが接合強度の解析には適していることが分かる。下図は、角度シェアモードで試験した各はんだバンプの接合強度を示している。鉛フリーはんだは、従来のPb-Sn系共晶はんだに比べて接合強度が高いことが明白である。特に、Sn-Ag系の場合、直径は小さいながらも接合強度は極めて高い。はんだバンプの接合信頼関の観点では、接合強度の高さは必須であるが、他にも、繰り返し疲労耐性やエレクトロマイグレーション耐性、腐食耐性などの様々な評価基準が存在する。これらを総合的に評価しながら、はんだ材料の最適化は現在も進められている。

電子材料における接着・接合技術として、今後の5G世代のプリント基板技術として必須となるはんだ接合技術について述べた。特に、実用面で有効な接合強度試験法に注目して、その解析の重要性を述べてきた。正確な接合強度の評価手法が確立されてこそ、実効的な不良対策も実施できることとなる。今回の角度シェア剥離法は、はんだバンプだけでなく、ワイヤーボンド、電極膜および電極配線の付着性などにも幅広く応用が可能である。
参考文献
(1) 能瀬春雄 他、鉛系および非鉛系はんだの引張・圧縮低サイクル疲労き裂進展挙動(日本機械学会論文集A編68巻665号、2001.
(2) 高橋武彦 他、各種鉛フリーはんだの引張特性、9th Symposium of“Microjoining and Assembly Technology in Electronics” Febuary 6-7,2003,Yokohama, pp203-208.
(3) 谷口文彦 他、FBGAのはんだ接合部の熱疲労および機械的信頼性、(エレクトロニクス実装学会誌、2001)pp56~62.
(4) 荘司郁夫 他、Sn-Ag系Pbフリーはんだを用いたマイクロ接合部の熱疲労組織、(エレクトロニクス実装学会誌、2001)pp133~137.
(5) T.Y.Lee and K.N.Tu , Electromigration of eutectic and SnAg3.5Cu0.7 flip chip solder bumps and under-bump metallization, (JOURNAL OF APPLIED PHYSICS, VOLUME 90, NUMBER 9, 1 NOVEMBER 2001) pp4502-4508.
(6) 河合 晃、大澤義征:角度制御型シェアモード剥離法によるはんだバンプの付着性解析、日本接着学会第41回年次大会、2-3、講演要旨集、p237(2003).
(7) 河合、大澤、付着強度試験方法および装置、特許出願 (2003).
微小気泡
微細パターンによる微小気泡の付着脱離解析

半導体集積回路(LSI)や液晶プラズマ表示機器に代表されるように、電子デバイス産業の発展の歴史は注目に値する。電子デバイスの作製には、多くのプロセス技術の集合と最適化が不可欠であるが、その中でも、デバイスの設計基準に直接関わる光リソグラフィ技術の発展は欠かせない。このプロセスは、右図のように、マスク作製、レジストコート、プリベーク、パターン露光焼付け、アルカリ現像、純水リンスから成り立っている。そして、現像されたレジストパターンを用いて、下地基板をエッチングして金属配線を形成する。その後、マスクとなったレジストパターンは除去される。ここで、エッチングには、ドライエッチングとウェットエッチングがある。また、めっきプロセスによって、レジストパターン間に金属配線を形成するリフトオフプロセスも実用化されている。以上のように、光リソグラフィには様々なウェットプロセスが関与するが、もし、レジストパターン間に気泡が付着した場合、現像不良やエッチング不良、および、めっき不良を引き起こす。下の左図はレジストパターン上への気泡付着の具体例を示しているが、気泡は安定してパターン上へ付着する。また、下の右図にあるように、気泡サイズが小さいほど、レジストへの付着率は増加する。ここでは、レジストパターン上の微小気泡の付着メカニズムと脱離特性について述べる。

(光学顕微鏡写真)



レジストパターンに捕獲された気泡の脱離特性を解析するには、まず、光リソグラフィによって微細な凹型の正方パターンを形成する。右の上図には、作製した正方パターンの構造と顕微鏡写真を示している。基板はCu膜であり、パターンはドライフィルムレジスト(DFR)で作製している。DFRは、メッキ工程で使用される代表的なレジスト材料である。マスク設計に基づいてパターン作製しているため、凹部の容積を正確に決定することができる。すなわち、この容積とほぼ同等の体積の気泡を形成できる。下図は、このパターンを純水中に浸漬させた場合の顕微鏡写真を示している。正方パターンの内部に気泡が捕獲されているのが確認できる。次に、この状態に、エタノールを徐々に添加して、気泡が脱離する様子を観察する。当初、気泡はパターン側壁に付着して歪んだ形状をしているが、40%のエタノール濃度になると、側壁への付着は減少し気泡は球形に近くなる。また、60%以上でパターンからの気泡の脱離が始まり、70%では、全ての気泡が脱離している。このように、徐々にエタノールを注入して、溶液の表面張力を減少させた場合、捕獲された気泡が浮遊していく様子が明確に分かる。この気泡の脱離現象を異なるパターン容積において測定した結果を、右の下図に示している。パターン容積が小さい場合ほど、気泡は脱離しにくくなる。これらの現象は、系の自由エネルギー変化に基づいて説明することができる。一般的に、系の自由エネルギーの低くなる方向へ現象は移行していく。この場合、レジストパターンから微小気泡が脱離することにより、系の自由エネルギーは減少していく。


ライン状のレジストパターン内の凹部に捕獲された気泡は、パターン内を容易に移動する。右図のように、レジストパターンの凹部をライン状に形成した場合、気泡はライン内を移動し、パターンエッジ部で凝集する。ここで、パターン長さと幅は4mmと500μmであり、深さは50μmである。パターンの材質はDFRであり、基板はガラスである。一方、YとT形状パターンでは、中心角度が90度の場合に、気泡は中心に凝集するが、60度になるとパターンエッジ部に気泡は移動する。これは、中心部のパターン構造によって、自由エネルギーが変化し、気泡の安定性が変化していることを示している。このように、微細パターンにより微小気泡の付着脱離を定量的に解析できる。
参考文献
- Akira Kawai, "Adhesion Mechanism of Micro Bubbles on ArF and F2 Excimer Resists", J. Photopolymer Science and Technology, 17・5, 713-714 (2004).
- Akira Kawai, "Condensation Mechanism of Micro Bubbles Depending on DFR Pattern Design", Microelectronic Engineering, 83, 1167-1169 (2006).
マイクロチャネル/チューブ網における気泡トラップ解析
一般に、マイクロ流体デバイス中にトラップされる気泡は、滞りのない流体の流れに支障をきたすことが知られている。たとえば、人工毛細血管への応用では、血液の遮断や流路の閉鎖など致命的な欠陥につながる恐れがある。ここでは、気泡トラップ機構の解明を目的として、気泡の凝集メカニズムについて実験的な解析を行う。

(a)液滴の滴下 (b)液滴の注入

実験では、(a)マイクロチャネルパターンへの純水滴下実験、(b)高速度カメラ観察下のマイクロチューブへの純水導入実験、(c)環境制御型電子顕微鏡(ESEM)によるチャネル上の気泡観察を行っている。上の左図に(a)、(b)の実験概念図を示す。マイクロチャネルパターン、ホールアレイは膜厚が50μmのDFR(Dry Film Resist)を用いて、上の右表に示すプロセスで作製している。実験(a)では、線幅100μmの直線、Y型、T型、同心円型のチャネルパターンを採用している。実験(b)では、幅200μmのT型チャネルパターンにスライドガラスをのせ、シリンジを用いて純水を導入し、分岐点での純水の接触線を高速度カメラ(250fps)により観察している。実験(c)では、幅10μm高さ50μmの V型チャネルパターン上に、ESEMの冷却ステージを用いて水を発生させ、V型頂点での水の挙動をビデオ撮影している。

上表には実験(a)、実験(b)の観察結果を示している。気泡は直線チャネルでは片方のチャネル端に凝集し、Y型では二つの端に分かれて凝集している。しかし、T型では気泡はチャネルの交点に凝集する。これは、チャネル特有のピン止め効果の影響であると考えられる。同心円形状では、チャネルごとに気泡が凝集し、時間経過と共に気泡が移動する。実験(b)では、T型チューブ内の液体の伝播を観察することができる。また、下図にESEM写真と実験(c)のESEM画像を示す。ESEMにより、10μmのV型チャネルの頂点における気泡生成過程を確認することができる。

線幅100μm、10μmのDFRチャネルパターンにおいて、パターン上の気泡生成過程をin-situ観察により明らかにすることができる。また、T型マイクロチューブ内における液体の伝播を高速度カメラにより観察することができる。
塗布乾燥欠陥
接着層のピンホール(VF(viscos finger)変形)
接着剤で接着された界面を、そのままの状態で見ることは容易ではない。はたして、その界面はどのようになっているのか?通常のコーティングは基板や基材表面に行うが、接着剤のように2枚の基板で挟まれたり、狭ギャップ間に塗膜を形成する場合も多い。その際、接着層や塗膜に含まれる溶剤の蒸発コントロールは、固体の乾燥を扱う上で重要となる。一般に、高分子膜などの凝集性の低い固体中にガスが急速に発生した場合、Viscous Finger(VF)変形として知られるフラクタル的な粘性指状の変形が生じる。これは発生したガスによって, 高分子膜自体に粘性変形が生じ、多数のピンホールを形成することである。このガスは高分子膜の溶剤、および熱分解による反応生成物である場合が多い。このガスの圧力は非常に高く、固体の凝集性を超える場合が多い。



ここでは、接着層を剥離して、VF変形の状態を観察しよう。上の左図のように、ガラス基板上に, 溶剤系高分子膜をスピンコート法で膜厚10μmに形成し、他のスライドガラスで挟んで試料とする。高分子膜の主成分であるノボラック樹脂の熱軟化温度は約150℃であり、溶剤のエチルセルソルブアセテートの沸点は156℃である。次いで、これらの試料をホットプレートにより熱処理を行う。そして、剥離試験機を用いて界面を破壊し、剥離表面を観察する。剥離面には、上の右図のように熱処理により生じた円形のVF変形が多く観察できる。これは、高分子膜内の溶剤の蒸発に伴う局所的な圧力増加に起因し、付着面積の減少となり付着性は低下する。このような溶剤蒸発に伴うVF変形は、右図のように、Saffmanのモデルで解析できる。一般に, 流体の変形はナビエ・ストークス方程式に基づいて解析し、その時のギャップ間の流体内の圧力Pは、ラプラス場(∇2P=0)として表される。そして、流体内でのVFパターンの成長速度νは下式で表される。
ν = ( -b2 / 12η ) ∇P
ここで、 bはギャップ間隔、ηは流体の粘性係数を表す。ここで、急速な熱処理は高分子膜内での圧力勾配∇Pの増大を意味するため、成長速度νは大きくなりVFパターンの成長が顕著になる。一方、熱処理温度の上昇により、熱重合に伴う高分子膜の粘性係数ηの増加が考えられる。そして, 成長速度νは減少しVFパターンの成長が遅くなる。しかし, 実際には熱処理により高分子膜の凝集性が増加し、局所的な応力分布が生じると考えられる。よって、高分子膜内の応力分布とVF変形との相関の検討も必要である。ここで定量的にVF変形を解析しよう。VF変形モデルにより、VF変形の曲率半径ρとギャップ間隔bの比は下式となる。
ρ / b = ( Ca)-1/2
ここで、Caはキャピラリー数と呼ばれ、ギャップ間の流体の運動の特徴を表す無次元の値である。
Ca = η /νγ

VF変形パターン
ここで, γは粘性液体と基板間の界面エネルギーである。右図の観察結果から, ρ≒0.1mmでb=10μmであるため Ca≒0.01となる。ここで、Ca=0.3以下である場合は、流体の流れは粘性的であると考えられる。(0.3以上であれば, 透過性であると考えられる。) また、η=60cp, γ=40mJ/m2が得られ、 Ca=0.01とするとVF変形の成長速度vは約6.7×10-3m/sになる。VF変形現象を解析することで、界面での粘弾性を定量化できる。このように、固体内に生じる気体の制御は、乾燥技術において重要である。最近では、X線CTなどの非破壊検査技術が発達し、固体内部の構造をサブミクロンの分解能で解析できるようになった。これまで、未知とされていた現象も詳細に解析できるため期待が大きい。
参考文献
- P.G.Saffman and G.I.Taylor, Proc. Roy. Soc. A245 312 (1958)
- Akira Kawai,“Viscous finger pattern formed in photoresist film during heat treatment”, J. Photopolymer Sci. Technol, 17, 103-104 (2004).
ピンホールは拡張モードで解決する

(中心に点欠陥が存在する)
濡れコントロールは、塗工液と基板との界面相互作用が基礎となる。基板上の濡れ性解析は洗浄・乾燥・接着におけるトラブル低減に効果がある。ここではピンホール形成のメカニズムと対策について紹介する。薄膜形成法の一つであるスピンコート法は、その均一性の良さ、および量産プロセスへの適合性のため様々な分野で用いられている。この手法は、大規模集積回路 (LSI) や大型表示デバイスの製造技術であるリソグラフーにおいても、LSI基板上への高分子膜の塗布やパターン現像時のウエット処理に用いられる。ここでは、高分子膜のスピンコート中に発生する大面積ピンホール (濡れ不良) に注目する。使用した高分子膜には、ノボラック樹脂、溶剤、感光剤が含まれている。スピンコート用基板として、6インチサイズのシリコン酸化膜(スピンオンガラス:SOG)基板を用いる。右図は高分子膜に生じたピンホール写真を示している。ピンホール部は、直径約250μmの範囲にわたり高分子膜が濡れていない。また、ピンホール中心部には大きさ数10μmの異物が存在している。よって、高分子膜が遠心力で基板上を拡がる際、異物によって高分子膜の連続性が失われピンホールが形成される。このピンホールはウェハ中心部より外周部に多く発生し、ウェハ回転時の遠心力が一要因となっている。結果として、下図のように、高分子膜の表面張力により膜の収縮が加速され、ピンホールはデバイス製品全体に拡大される。ピンホールの防止には、拡張濡れモードによる対策が有効である。



ここで、ピンホールの発生メカニズムを考察する。上の左図は、発生したピンホール数のSOG基板の熱処理温度依存性を示している。175℃以上の熱処理によって、ピンホール数が急激に増加する。また、上の右図はSOG基板の表面自由エネルギーの熱処理温度依存性を示している。SOG膜の表面自由エネルギーは熱処理温度の増加と共に低下している。また、熱処理温度の上昇に伴い極性成分は減少し、分散成分は逆に増加する。そして、高分子材料の各成分値に徐々に近くなる。SOG膜の表面エネルギーの減少は極性成分が主な要因である。ここで、高分子膜のピンホールが発生する175℃での値は37.5mJ/m2である。ここで、基板表面の高分子膜の拡張係数S、および濡れ仕事Waは下式で求められる。
Wa = γ1 + γ2 - γ12
-S = γ1 - γ2 - γ12
ここでγ1、γ2、γ12は、それぞれ基板と高分子膜の表面エネルギー、および界面エネルギーを表している。下表に高分子膜の拡張係数Sと濡れ仕事Waを示している。拡張係数Sは熱処理温度範囲で正の値となり、高分子が拡がりにくい状態である。この傾向は熱処理温度の増加とともに強くなる。同様に濡れ仕事Waも熱処理温度の増加とともに減少する。拡張係数Sと濡れ仕事Waの挙動から、SOG膜の熱処理温度の増加に伴い高分子膜のピンホールは発生しやすくなる。

以上のように、SOG膜上での高分子膜のピンホール発生要因について、以下のように考察できる。
(1)SOG膜上の異物がきっかけとなり, 高分子のピンホール核が形成される。
(2)高分子材料の拡張係数S, 濡れ仕事Waによる考察から, SOG膜の表面エネルギー変化によりピンホールが安定化される。高分子膜のピンホール形成に関しては、基板の表面エネルギー制御が重要となる。
参考文献
- 河合 晃、”有機スピンオンガラス上でのフォト高分子の濡れ不良”、日本接着学会誌、30, 582-585 (1994).
塗膜のクラック発生を抑制する
乾燥とは、塗工液が高品位にコーティングされた後に、残存溶剤を塗膜から除去する工程である。この際、僅かな溶剤にはラプラス力が働き、塗膜の凝集性を上げる働きをする。しかし、体積変化による応力が発生し様々なトラブルの原因となる。また、乾燥装置によっては塗膜内の乾燥不均一を生じる。一般に、塗膜の表面には硬化層が存在し、膜歪みの原因となる。ここでは、乾燥プロセスに起因する様々なトラブルや欠陥について紹介し、そのメカニズムと対策を解説する。特に、塗膜のクラック、局所剥離のポッピング、高分子膜の表面硬化層、溶液との接触による環境応力亀裂(クレイズ)に注目する。

塗膜を積層することで、応力マッチングや粘弾性制御に有利になる場合がある。しかし、各層の残留溶剤の乾燥制御が不十分の場合、クラック等の歪みを発生する。ここでは、無機-有機積層膜における熱処理条件とクラック発生について、その要因と解決策について述べる。右図は、段差基板上にノボラック樹脂の厚膜層(下層)をコートし、その上にスピンオングラス(SOG)と呼ばれるゾルゲル法で形成するガラス膜(中間層)をコートした様子を示している。実際のプロセスでは、中間層の上に微細加工用のフォトレジスト層(上層)がコーティングされる。これは、半導体集積回路(LSI)の微細加工プロセス分野で実用化されている「三層レジストプロセス」の基本構造である。下層をコートすることで、基板の段差を平坦化できるため、上層のパターン形成に悪影響を与えない。3層とも溶剤を含んでいるため、乾燥条件の設定が重要となる。

上図は、下層の上にSOG中間層をコーティング後に熱処理を行った際のクラック模様である。これらは光散乱方式の表面形状測定装置で観察できる。基板は6インチサイズのシリコン基板である。SOG中間層の熱処理温度の増加に伴い、クラックが多く発生している。クラックはウェハ周辺部から発生し、中心へ向かって成長することが分かる。よって、クラックの発生の核はウェハエッジに多く存在し、ここでは塗膜が不連続になっている。

上図は、下層膜とSOG中間層との熱処理温度条件と、クラック発生領域をまとめたものである。低沸点溶剤を含む下層材料(a)では、下層の熱処理温度をSOG中間層が超えた場合にクラックが発生している。これは、下層から残存溶剤がガスとなって発生し、SOG膜を押し上げたことが原因である。高沸点溶剤を含む下層材料(b)では、溶剤の沸点を高め、かつ軟化性を高めた下層材料を用いている。下層より高い温度で熱処理しても、SOG中間層にクラックが生じていない。このように、多層膜のクラックは単独の要因で発生することは少なく、基材や下層等の膜との歪みバランスによって制御できる。


塗膜中に溶剤が徐々に発生すると、クラックが発生し成長する。しかし、急激に塗膜内にガスが発生すると周囲へ拡散する余裕がなく、局所的にガスが発生し歪みを生じる。その結果、局所的に膜が剥離することがあり、これをポッピングという。上図はノボラック樹脂を主成分とするレジスト膜に生じたポッピングの写真である。基板はWSi2膜である。ポッピングはウェハ周囲に多く発生している。レジストの溶剤はエチルセルソルブアセテートであり、沸点は156℃である。このポッピングはレジスト膜に紫外線を照射した場合に発生する。感光性樹脂であるレジスト膜は、紫外線に感度を有する感光剤(ナフトキノンジアジド)を含んでいる。紫外線照射によりケテンを経て、インデンカルボン酸へと変化していく。これがアルカリ水溶液への浸漬により、酸-アルカリ反応によって紫外線照射したレジスト領域が溶解する。この光化学反応過程において、レジスト層には窒素ガスが発生する。窒素ガスは急激なレートで発生するため、レジスト膜と基板との界面に窒素ガスが集中し、膜を押し上げることでポッピングが生じる。よって、右図のモデルのように、窒素ガスの集中により生じた歪エネルギーと、レジスト膜と基板との付着エネルギーとのバランスにより発生要因が説明できる。上図のように、ウェハ周囲にポッピングが多く発生するのは、ウェハエッジ周辺での膜歪みが大きいためである。しかし、付着エネルギーが歪みエネルギーを上回れば、ポッピングは回避できる。あるいは、窒素ガスの発生レートを低くする、すなわち、紫外線の照射レートを低減することにより、歪エネルギーを下げることが可能となる。局所的に発生した窒素ガスの圧力は約8気圧となり、瞬間的に高圧領域が生じることとなる。

上図は基板の表面エネルギーとポッピング発生との関係を示している。各種酸化膜や窒化膜およびシリサイドが基板として用いられ、これらは基本的に極性成分が高い(上図(a))。ここで、WSi2膜に注目し、HMDS(ヘキサメチルジシラザン)を用いたシランカップリング処理を施してみる。この処理によって、極性成分の低下が確認できる。WSi2膜表面に残存しているOH基が疎水基に置換されたことに起因している。しかし、シランカップリング処理により、レジスト膜と基板との直接の付着力は低下する。上図(b)には、付着エネルギーWaとポッピング数との関係を示している。付着エネルギーWaの増加に伴い、ポッピング数が低減することが分かる。しかし、シランカップリング処理により、基板との付着エネルギーが低下するため、ポッピング数が増大することが分かる。このように、塗膜の付着要因と剥離要因の制御がトラブル解決の近道となる。

された環境応力亀裂
(6インチサイズウェハ)
一般的に、スピンコート法はその均一性, プロセス, 装置の簡易さにより多くの産業で用いられている。膜厚均一性を向上させるにはスピン回転数の上昇が効果的であるが, そのためウェハ周辺部の周速度は速くなり、レジスト膜からの溶剤蒸発の不均一性を引き起こす。レジスト膜をアルカリ現像液へ浸した場合に, 未露光部のレジスト表面に微細なひび割れが生じる。この現象はウェハの大口径化に伴い顕著になる。また, この現象は、応力歪みを有した高分子膜に溶液が触れる際にクラックが発生する環境応力亀裂 (Environmental Stress Cracking) である。ここではレジスト膜中に発生した微細亀裂の発生機構を、レジスト膜中の残留溶剤量に注目して解析する。使用したレジスト成分は、ノボラック樹(m-クレゾール, p-クレゾール), 感光剤 (ナフトキノンジアジド), 溶剤 (エチルセルソルブアセテート) の混合物である。右図はウェハ内での代表的なレジスト亀裂分布を示している。この図は肉眼によるスケッチであるが、TMAH水溶液中に浸漬させて約5秒程度で発生する。光干渉効果により亀裂部のみが変色して見えるため、肉眼で確認することが出来る。ウェハの中心部では亀裂はほとんど発生せず、ウェハ周辺部に多く発生することがわかる。また亀裂はウェハ中心に対して同心円状に発生し、その長さも周辺部ほど長いことがわかる。これらより、レジスト膜内の応力分布が影響していることが分かる。


上の左図は表面粗さ計で測定した亀裂部の断面形状を示している。亀裂の幅は約100μmであり, 最大深さは約60nmである。レジスト膜の表面粗さは数nmである事からも、亀裂はかなり深いことがわかる。環境応力亀裂のモードにはクラックおよびクレイズがあるが、この亀裂は完全な膜分離に至っていないためクレイズであるといえる。すなわち, この亀裂の発生原因はレジスト膜表面が収縮したことによる凝集破壊である。また、亀裂部のレジスト膜は正常部より薄くなるため, 後工程のドライエッチング中にレジストの膜減りが生じ加工精度に影響を与える。上の右図はTMAH水溶液中でレジスト膜に発生した環境応力亀裂の発生機構を示している。(a)のように、TMAH水溶液中のレジスト膜表面にはクロスリンク(架橋)が生じ、 残留溶剤量の多いウェハ中央部では膜収縮が顕著に起こる。その結果、(b)のように強い引張り応力が, ウェハ周辺部のレジスト膜表面に生じる。ウェハ周辺部の表面クロスリンク層は薄いと予想されるため, レジスト膜表面のみの凝集破壊が起こり亀裂発生に至る。よってレジスト膜内の残留溶剤量のコントロールは, 亀裂発生を防止する上で重要な要素となる。
参考文献
- Akira Kawai, "Local Peeling of Photoresist Film during Ultraviolet Light Exposure", Jpn. J. Appl. Phys. 33, L149-L151 (1994).
- Akira Kawai, "Blister Formation at photoresist-Substrate Interface" ,Jpn. J. Appl. Phys. 33, 3635-3639 (1994).
- 河合 晃, "レジスト膜上のスピンオンガラス膜に発生する微細亀裂" ,日本接着学会誌, 31, 498-501 (1995).
- 河合 晃, "TMAH水溶液中でレジスト膜に発生した環境応力亀裂" ,日本接着学会誌, 31, 452-457 (1995).
- Akira Kawai, "DUV Hardened Layer of Resist Dot Pattern Detected by Tip Indentation Method" ,J. Photopolymer Science and Technology, 14, 749-750 (2001).
- Akira Kawai, "Resist Hardening by Electron Beam Irradiation Analyzed by Atomic Force Microscope" ,J. Photopolymer Science and Technology, 14, 751-752 (2001).
- Akira Kawai , "Cohesion property of resist pattern surface analyzed by tip indentation method", J. Photopolymer Sci. Technol, 17, 441-448 (2004).
乾燥むらは乾燥時の対流が原因である
液晶パネルや太陽電池パネルの大型化に伴い、大面積対応のコーティングプロセスの高精度化が求められる。パネル面内の膜厚および膜質均一性は、重要な管理パラメータである。しかし、右図のような乾燥むらと称するコーティング後の濃淡模様が製造上の問題となっている。この乾燥むらも、液体内対流が原因で生じる。乾燥むらの濃淡は、以下のように、塗膜の僅かな膜厚変化を反映している。
Δd = λ / 4n

ここで、Δdは濃淡領域の膜厚差、λは光の波長、nは波長λにおける塗膜の屈折率である。高分子膜の場合、可視光線(λ=500nm)、屈折率n=1.6とすると、濃淡の膜厚差Δdは78nmとなる。よって、右図のように、コーティング後の乾燥むらの濃淡は、約80nmの膜厚差を反映していることとなり、液晶パネルなどの光学デバイスにおいては製造上の問題となる。下図のように、乾燥むらは塗工液内の溶剤が乾燥中に対流し、同時に樹脂成分を移動させることで生じる。液滴の場合と異なり、塗工膜は面積が大きいため、各セグメントに分かれて対流が生じる。このセグメントはベナールセルと称し、日常的にもよく観察される。身近なところでは、味噌汁などの溶質を含む液体を観察すると、分割したセル模様が見られる。理想的な条件下では、六角形の集合体として観察できる。対流による乾燥むらは時間経過とともに過剰になる。よって、塗膜の乾燥むらを防ぐには、コーティング後の速やかな乾燥が必要である。

参考文献
- Akira Kawai, "Formation factors of watermark for immersion lithography", Jpn. J. Appl. Phys. 45. 5383-5387 (2006).
ウォータマーク(乾燥痕)の生じる原因

メガネや車のフロントガラスに、右図のような円形の雨水のウォータマーク(乾燥痕)が生じることは知られている。様々な形があるが、輪のような形状がほとんどである。このウォータマークの形状には理由がある。主な要因は、乾燥時に生じる液滴内の対流と、液滴コンタクトラインのピンニングである。ここでは、比較のために、液滴中の微粒子の有無について考察する。


上図は、超清浄なシリコンウェハ上に滴下した超純水液滴の乾燥過程を示している。観察はスーパークリーンルーム内で行っている。よって、基板や液滴中の微粒子は極端に少なくなっている。乾燥とともに液滴サイズは縮小し、液滴周囲(コンタクトライン)もほぼ円形を保ったまま小さくなっている。最終的には、液滴の中心部分に凝集したウォータマークが形成されるが、その大きさも小さい。このウォータマークは、液滴中に溶解していた物質や僅かに残存していた微粒子が凝集したものである。液滴の乾燥時には、右図にあるように対流が生じる。液滴内では中心部は下向きに対流し、基板近くでは周囲へ向かって流れ、最終的に中心部の頂上に戻る。これは、液滴の乾燥に伴う気化熱により液滴表面の温度が低下することに起因している。冷却された液体は基板方向へと対流するが、液滴中心部の対流が周辺部より体積効果のため増大し、このような対流モデルとなる。ホットプレートなどで液滴を加熱した場合は、液滴内対流は逆方向に生じる。

ここで、上図には、液滴内に微粒子が分散している場合の乾燥挙動を示す。微粒子はPSL(ポリスチレンラテックス)であり、液体中では特定のゼータ電位で帯電している。この帯電により、微粒子は液体中では凝集しにくく、対流とともに移動できる。PSLの純水中でのゼータ電位は、-50mVである。微粒子が分散している液滴は、乾燥に伴い微粒子が中心部から周辺部へ移動する様子が観察できる。これは上述の対流のためである。また、乾燥が終わるまで液滴の大きさは変わらない。特に、コンタクトライン付近に微粒子が多く凝集しており、これがウォータマークが輪の形成理由である。この乾燥モデルは下図のように説明できる。乾燥に伴い、液滴中の微粒子は対流とともにコンタクトライン近傍に凝集してくる。このとき、一部の微粒子は乾燥により基板に固着し、液滴内に戻らない。そして、このコンタクトライン上の微粒子がピンニングとなり、液滴コンタクトラインの縮小を妨げる。液体のピンニング効果は、液体の拡張および後退を妨げる働きをする。よって、液滴の乾燥は元のコンタクトラインを維持しつつ進行する。対流によって、次々と微粒子がコンタクトラインへ凝集するため、大きい輪の形状を形成する。この時、ゼータ電位の存在により、微粒子はコンタクトライン以外のシリコン基板中に付着せず移動する。これは、純水中のシリコン基板表面のゼータ電位が-60mVであり、PSL粒子のゼータ電位と同極であるため反発力が生じるためである。ウォータマークを低減するには、まずは液滴中に含まれる微粒子数を低減させることが効果的である。他には、ピンニング効果の低い低表面張力液体を溶剤として用いることが考えられる。超LSIや液晶デバイスプロセスにおいて、IPA(イソプロピルアルコール)蒸気乾燥が採用されているのはこのためである。

参考文献
- Akira Kawai, "Formation factors of watermark for immersion lithography", Jpn. J. Appl. Phys. 45. 5383-5387 (2006).
塗膜内のガス発生により微小剥離が生じる
液晶や半導体デバイスプロセスに用いられている高分子膜は、ポリマーの特性を生かした特殊な実用例であると言える。高品質でかつ無欠陥の高分子パターンを得る事は、製造においても重要な課題である。1983年にLongがポジ型高分子膜(フォトレジスト)にLSIパターンを紫外線で焼き付ける際にボイドが生じる事を初めて報告した。この現象は、最近の高解像高分子において顕著に見られている。しかし、このボイドの発生機構は、まだ十分に解析されていない。ここでは、ボイド形成ファクターとして、高分子膜中の感光剤濃度、及び付着エネルギーの2つに注目し、そのメカニズムを考察する。これらのファクター依存性を調べるため、感光剤濃度を変えた種々の高分子、及び表面エネルギーの異なる無機基板を用いてボイド発生実験を行った。高分子中の感光剤が光分解する際に生じるN2ガスによって、局所的に高分子膜が基板との付着力以上に押し上げられた時にボイドが発生すると考えられる。
感光剤濃度の異なる3種類の試作ポジ型高分子膜と市販のポジ型高分子膜の4タイプを実験に用いた。無機膜として、WSi2,SiO2,SiN膜をSi(100)6インチウェハにスパッタリング法,熱酸化法,CVD法によって各々形成した。また、Wsi2上にシランカップリング剤としてHMDS(ヘキサメチルジシラザン)のプライマー処理を行ったものも用いた。高分子膜は1μmの膜厚となるように、スピンコート法で形成した。ウェハ上の高分子膜の全領域に、ブランクマスクを用いてg-線用縮小投影露光機で紫外光を照射した。分解率は透過率計による紫外光吸収法によって同定した。高分子/基板界面に発生したボイドはパーテイクルカウンターを用いて計測した。
表面エネルギー理論を用いて、高分子膜/基板間の付着エネルギーを求める。下式より付着エネルギーは次のように表される。
EA = 2 ( αr αs + βr βs )
ここで高分子膜1とSi基板との場合、上式より付着エネルギーを次のように求める事ができる。
EA = 2 ×(5.64×5.20+3.11×4.13) = 84.4 erg/cm2
発生したN2ガスによって高分子膜が受ける歪エネルギーを以下の手法で求めた。歪エネルギーを求める際に、次の2つの仮定を行った。
1)高分子膜内に発生したNガスの全てが、高分子膜/基板界面に集中する。すなわち、高分子膜表面からの放出は考慮しない。
2)ボイドが発生したエリア(円形)の高分子膜に発生するN2ガスのみを考える。すなわち、発生したN2ガスの横方向の拡散はないものとする。

この計算に用いた各物理定数を上表にまとめた。一例として、高分子膜の感光剤が50%分解された場合を考察する。1μm膜厚で1cm2領域に発生したN2ガス体積Voは、
VO = GO / DO = 7.29 × 10-4cm3
となる。この値は、この領域の高分子膜の体積の約7倍にあたる。この体積のN2ガスが瞬時に発生するため、高分子膜はかなりの圧縮応力を受けるものと考えられる。よって、凝集力が弱い基板との界面に発生したN2ガスが集中する。そして、高分子膜を押し上げ、ボイドを形成する。ボイド発生を引き起こすN2ガスの体積VBは
VB = VO× SB = 3.3×10-7cm3 (1)
となる。発生したボイドの内圧PB(応力σB)は以下のようになる。
PB(σB) = (VB/ V1) × 1atom = 7×107 erg/cm3 (2)
この内圧(応力)より高分子膜が受ける歪エネルギーeBは、
eB = σB2/2E = 82.8×104 erg/cm3 (3)
となる。1μm膜厚の高分子膜の場合、歪エネルギーESは
ES = eB×tr = 82.8 erg/cm2 (4)
となる。
下の左図(a),(b)には紫外光照射後に高分子膜/基板界面に発生したボイド写真を示している。ボイド形状は直径100から300μmのほぼ円形である。(a)のように高分子膜の浮き上がりによる干渉渦だけでなく、(b)の様な完全に高分子膜片が飛び散っているものも見られている。また、ウェハの中心部より外周部の方が、多くのボイド発生が見られる。ボイドは紫外光照射した領域のみに発生し、未照射部には発生は見られない。よって、高分子膜内に発生したN2の放出過程がボイドの発生に密接に関係していると推定できる。下の右図には、ボイド発生メカニズムをフローチャートで示している。(a)高分子膜が基板上に均一に塗布・形成されている。(b)膜全面に紫外光を照射する。(c)発生したN2ガスは拡散し始める。その放出速度は感光剤濃度に比例する。(d)発生したN2ガスは高分子膜表面から放出されていく。ここでN2ガスの発生レートが放出速度よりもかなり大きい場合、N2ガスは高分子膜/基板界面のような結合力の小さい領域へ集中する。このN2ガスの発生によって、高分子膜は過剰な圧縮応力を受ける事となる。結果として、このN2ガスによって、高分子膜は基板から引き離される方向に応力を受ける事となる。よって、(e)高分子膜の凝集破壊が生じ周囲へ飛散する結果となる。もし、高分子膜と基板の付着力が高ければボイドの発生は見られず、N2ガスは横方向へ拡散していくと考えられる。ボイド形成に関与するファクターとして、以下の3つが考えられる。それは、(i)N2ガス発生により生ずる高分子膜の歪エネルギー、(ii)高分子膜と基板との付着エネルギー、(iii)紫外光照射時の高分子膜中でのエネルギー効率である。ここで、ボイドは高分子膜の歪エネルギーEsが付着エネルギーEAを超えた時に発生すると仮定する。(i)に関する物理量として、(1)N2ガスの発生量(これは高分子膜内の感光剤濃度に対応する。)、(2)N2ガスの放出レート、(3)高分子膜の弾性定数が挙げられる。(ii)については、(1)表面自由エネルギー、(2)表面粗さ、(3)高分子膜と基板とのストレスマッチングなどがある。(iii)としては、(1)紫外線照射全エネルギー量、(2)照射面積、(3)照射エネルギー密度がある。ここでは、上記のファクターの中で(i)と(ii)の2つに注目した。



右図は、高分子膜内の感光剤濃度とボイド発生量との相関を示している。感光剤濃度はモル分率に対応した任意単位(a.u.)で表している。1種類の高分子膜に対して、6枚のウェハのデータ値を示している。黒丸1ヶはウェハ1枚のデータを表している。感光剤濃度が増加するにつれ、ボイド発生量も増加する。また、そのばらつきも増加している。これより、感光剤濃度は要因の1つとなりうる事がわかる。他の要因として、高分子膜と、無機基板との付着エネルギーEAを考察する。付着エネルギーを求めるために、各膜の表面エネルギー成分を求めた。下表、及び下の左図には各基板,高分子膜表面の分散α、極性βプロットを示している。空気の場合はα=β=0のポイントを意味する。高分子膜は全てα:5.62~6.02(dyn/cm)1/2の狭い範囲に集中している事がわかる。また、高分子膜は、無機基板と比べて低い極性値を示している。SiO2,WSi2,SiNの無機基板はSiよりも高い極性成分を示している。この極性成分は基板表面の-OH基等の極性基密度に対応していると考えられる。HMDSプライマー処理を行う事によって、極性成分がわずかに減少する事がわかる。たとえばWsi2の場合、6.12から5.11(dyn/cm)1/2へと減少する。全体的に各基板間の極性成分の差は、分散成分よりも明らかに広いことがわかる。よって、付着エネルギーに対し、極性成分は分散成分よりも強く影響する事が考えられる。下の右図は、高分子膜1の場合の付着エネルギーとボイド数との相関を示している。各基板との付着エネルギーは80~95erg/cm2の範囲の大きさになる事がわかる。付着エネルギーの増加と共にボイド数は減少している。よって、基板の表面エネルギーは、ボイド発生に密接に影響している事がわかる。




右図は、高分子膜/基板界面に生じる付着、歪の両エネルギーをベクトルで表したものである。ここで形成ファクターUとして、基板と高分子膜との付着エネルギーEAと歪エネルギーES(2つは互いに逆向きのベクトルを有する。)を用いて、次式のように定義する。
U = EA- ES
歪エネルギーESが付着エネルギーEAを超えた場合(すなわち、Uが0以下の場合)、高分子膜は基板より剥がされボイドが形成されると考えられる。逆にU値が0以上の場合には、ボイド形成は起こらないとする。そこで、2つのエネルギーEA, ESの各測定値から得られるU値を用いてボイド形成の推定を行う。下の左図は、種々の高分子膜と基板との組合せによる付着エネルギーEAを示している。高分子膜間には4erg/cm2の差が見られ、これは付着エネルギーの約5%に相当する。表面の極性が比較的高いSiO2基板の場合には、高分子膜と大きな付着エネルギーを示す。基板の極性成分に応じて付着エネルギーは変化する。次に、式(1)~(4)により求めた各高分子膜の受ける歪エネルギーを下の右図に示す。歪エネルギーは感光剤濃度の二乗に比例して増えていく。LSIの製造プロセスで用いられる50%の感光剤分解率では、高分子膜間の歪エネルギーEsの差は約30erg/cm2となる。これは高分子膜間の付着エネルギーの差4erg/cm2に比べてかなり大きい値となっている。よって、高分子膜間の歪エネルギーの差は、付着エネルギーに比べ形成ファクターUにより強く影響する事が考えられる。


下の左図には、種々の高分子膜と基板との組合せにおける形成ファクターUとボイド発生数との相関を示している。形成ファクターUは感光剤濃度の増加と共に線形に減少する結果となっている。Si基板の場合、U値が0erg/cm2以上になる高分子膜(2, 3)についてボイドが発生しないと予想される。一方、U値が0以下になるMCPR2000H, 高分子膜1の場合はボイドは形成されると考えられる。下の右図は、Si基板上でのボイド発生数と形成ファクターUとの相関を示している。下の左図でのU値による推定どおりにボイドの発生が見られている。よって、この形成ファクターUを用いて種々の高分子と基板との組合せにおけるボイド形成を予想する事ができる。また、感光剤濃度及び表面エネルギーをコントロールする事により、このボイド発生を防止する事が可能になると結論できる。


高分子膜/基板界面に紫外線照射中に発生するボイド形成について考察を行った。
1)高分子膜に発生した歪エネルギーによって、基板と高分子膜の付着は破壊され高分子膜が局所的に浮き上がる事によりボイドは形成される。
2)感光剤濃度と表面エネルギーはボイド形成の主要因である。
3)基板/高分子膜間の付着エネルギーと高分子膜の歪エネルギーの差で表される形成ファクターUは種々の高分子膜/基板の組合せにおけるボイドの発生を予想するのに適している。
参考文献
- Akira Kawai , "Local Peeling of Photoresist Film during Ultraviolet Light Exposure", Jpn. J. Appl. Phys. 33, L149-L151 (1994).
- Akira Kawai, "Blister Formation at photoresist-Substrate Interface", Jpn. J. Appl. Phys. 33, 3635-3639 (1994).
表面エネルギーと表面処理
表面現象と表面エネルギーと表面積依存性


液体および固体の表面には、表面エネルギーγと呼ばれる有限のエネルギーが存在する。表面エネルギーの定義は、物質の表面に存在する単位面積あたりのエネルギーでありJ/m2の単位で表される。この表面エネルギーが、物質の変形や亀裂などの力学的仕事として、あるいは酸化や汚染などの化学的反応として消費される。右図は固体の表面エネルギー変動について説明している。金属などの固体の本質的な表面エネルギーは2000~3000 mJ/m2であるが、酸化層、汚染層、吸着水などの表面層形成により、100 mJ/m2以下に低下する。ここで、表面エネルギーの低下は物質表面の安定化を意味している。すなわち、この表面エネルギーの変動が付着やコーティングといった機能的な仕事をする。表面層の厚さは通常4~5nmである。一方、ある物質の立体形状が決まれば、その表面積Sと表面エネルギーγの積により、物質表面が有するエネルギーの絶対値γ・S(J)が求まる。熱力学的には、定圧・定温の条件下では、このエネルギー(エンタルピー)が最小になるように現象が進行する。すなわち、同一体積の物質であれば、その表面積を最小にするように変形することとなる。液滴が球形になりやすいのは、この理由に基づいている。一方、表面エネルギーγの単位J/m2は換算するとN/mとなり、右表のように表面張力と呼ばれる力学的作用を表す。表面エネルギー(スカラー量)と表面張力(ベクトル量)とは、数値は同じであるが物理的意味が異なる。すなわち、物質の表面エネルギーが、亀裂や変形などの力学的仕事として消費される場合は「表面張力」として表現するのである。水の表面エネルギー(張力)は72.8mJ/m2であり、エタノールは22.3mJ/m2である。この表面エネルギーの値には、液体分子の分極性が強く反映されている。水分子のように双極子モーメントが高く、分子間相互作用が高い液体の表面エネルギーは高くなる。
ここで、表面エネルギーとサイズ効果について考える。微小サイズの物質に特有な現象として、下式に表される形状サイズ効果がある。すなわち、半径rの微小球を考えた場合、サイズの縮小に伴って、内部エネルギーEC[J]に対する表面のエネルギーES[J]の比率(表面の寄与率A)が高くなることである。

ここで、γCとγSは、それぞれ微小球の凝集エネルギー(J/m3)、および表面エネルギー(J/m2)を表す。γCおよびγSに球の体積および表面積をそれぞれ乗じることにより、エネルギーの絶対値が求められる。よって、下の左図のように、体積が同一のままで、微小球のサイズが縮小した場合、凝集エネルギーに対する表面エネルギーの占める割合が、球の半径rに反比例して増大することが分かる。すなわち、同一体積の微粒子の全てが半径rの微粒子に分割された場合、全体の表面積が飛躍的に大きくなる。よって、微小領域では、体積に基づく現象よりも表面の関与する現象が支配的になる。たとえば、下の右図にあるように、微粒子や微小液滴は、重力よりも表面の帯電や気流の影響を受けて、大気中を落下することなく永続的に浮遊することができる。雲や霧を構成する微小液滴などが浮遊するのは、この原理に基づいている。
近年のナノテクノロジーの発展において、我々はマテリアルの表面特性に注目する必要がある。マクロサイズにおける常識や経験は通用しない場合があり、表面特性を上手に制御していくことが重要となる。


参考文献
- Swalin, 上原他訳, 「固体の熱力学」 コロナ社 (1992).
- Akira Kawai, Masahito Hirano, J. Photopolymer Science and Technology, 20, 813-814 (2007).
凸部では濡れにくく凹部では濡れやすい

微小液滴の成長と消滅は、核生成モデルで説明できる。これは、右図にあるように、平面上で微小液滴が成長する場合、あるいは消滅する場合、臨界核と呼ばれる閾値が生じることを示している。系の全自由エネルギーを求めた場合、表面エネルギーと体積(凝集)エネルギーとの和は、ある大きさで極大を示す。この時のサイズが臨界核の大きさである。このサイズが液滴の成長および消滅時の最小サイズを与える。この臨界核サイズは、平面の凹凸によっても、影響を受ける。下図には、凹面、平面、凸面での液滴の全自由エネルギー曲線を示している。この場合、凸面では、臨界核サイズが大きいことが分かる。よって、突起などの先端部では液滴は成長しにくく、凹面形状では比較的成長しやすいことが分かる。これらは曲面基材へのインクジェット印刷などを行う場合、液滴サイズのコントロールに有効である。

シランカップリング処理による疎水化
固体表面の濡れ性制御は、疎水化処理と親水化処理に主に分けられる。疎水化処理として、シランカップリング処理やフッ素プラズマ処理が代表的であり、親水化処理は酸素プラズマ処理が有効である。一般に、表面エネルギーの分散および極性成分解析によって、物質の表面特性を表せる。また、液中での濡れ付着解析には拡張係数が有効である。ここでは、コーティング性に大きく関わるシランカップリング処理について述べる。シランカップリング処理は、基板表面の極性成分を低下させる作用がある。すなわち、基板表面に存在するOH基などの親水基を疎水基(親油基)に置換する。特に、コーティング膜の液中での安定性にシランカップリング処理は有効である。また、シランカップリング処理は真空系を必要としないため、設備は比較的簡略であり、汎用性の高い表面改質処理として位置付けられる。シランカップリング処理後の表面安定性も高く、実用的なプロセスとして、微粒子の分散、微細パターンの付着性、およびウェットプロセスでの浸透制御に用いられる。ここでは、シランカップリング剤として、半導体LSIプロセスや液晶パネルおよび太陽電池パネル作製に実績を有するヘキサメチルジシラザン(HMDS:hexamethyldisilazane、C6H19NSi2)を主体に解説する。

HMDSは無色透明で無害の液体であり、少し刺激性の臭気があるが取り扱いは比較的容易である。しかし、水分との反応性は高く、保存には注意を要する。化学的性質は上表に示すとおりである。プロセス上重要となる沸点は126℃である。HMDSのシランカップリング反応は、下の左図のように、シリコン酸化膜表面の親水基であるOH基を、疎水基である3CH3-SiO基へ置換する働きである。通常は、カップリング反応を促進させるため、HMDSを蒸気あるいはガス状にして基板上に供給する。HMDSを液体のままで高分子膜に散布するとゲル化反応を生じ、基材を損傷させる恐れがある。また、下の左図のように、シランカップリング反応過程においてアンモニアが発生する。アンモニアは、人体に有害だけでなく装置腐食を引き起こすため、排ガス処理を十分に行う必要がある。また、水分の影響を強く受けるため、処理プロセス中の湿度管理が重要となる。これらは、処理装置の構成において大きく影響する。このように、固体表面の疎水性および親水性の評価には、液体の濡れ性を表す接触角法が有効である。また、表面処理を定量評価するためには、表面エネルギーγ(mJ/m2) が適している。


上の右図は、シランカップリング処理による接触角の変化を示している。純水の接触角はシリコン酸化膜などの親水性表面では低くなるが、シランカップリング処理による疎水化によって高くなることが分かる。また、シランカップリング処理を行った表面の化学結合状態を調べるには、FT-IRやESCAなどの化学分析手法が有効である。下図は、FT-IR-ATR法で測定したシリコン酸化膜表面の解析結果を示している。シランカップリング処理に基づく疎水基に起因したピークが得られている。シランカップリング処理した試料の保存は、乾燥窒素および乾燥空気中の密閉容器、あるいは減圧チャンバー内が好ましい。これらの保存条件であれば、半日程度は表面特性を維持できる。1日以上経過すると徐々に親水性へ劣化していくので注意が必要である。

参考文献
- Akira Kawai, Junko Kawakami, "Wetting analysis of hydrophobic substrate treated by HMDS primer", J. Photopolymer Science and Technology, 20, 815-816 (2007).
シランカップリング処理の最適化
実用化レベルでのシランカップリング処理(以下、HMDS処理)では、バブリング方式などの気化プロセスが採用されている。これは、シリコン半導体ウェハおよび液晶用ガラス基板の大面積化に伴い、迅速で均一性の高い処理が求められるためである。また、気化プロセスは、HMDSの消費量を抑える上でも効果的である。HMDS処理の性能を効果的に引き出すには、気化方法、カップリング処理温度、処理時間、単分子化処理などの主なプロセスを最適化することが必要である。下の左図は、HMDS処理の代表的なプロセスフローを示している。このフローは、現在の半導体処理プロセスで実際に用いられており、処理装置構成に大きく影響する。主な処理パラメータは、HMDS処理時間および温度、カップリング処理促進用の熱処理などである。通常、これらは厳密にコントロールされている。処理表面の評価には、純水の接触角測定を用いる。下の右図は、HMDSの飽和蒸気処理を目的とした基本ユニットを示している。密閉容器中でHMDS溶液を自然蒸発させて飽和蒸気雰囲気を作り、近傍に設置した基板を処理する。HMDS蒸気が外部に漏れないように局所排気機能も有している。このシステムにより、処理時間は長くなるが、基板表面の単分子化処理が行える。後述するが、シランカップリング反応は表面の単分子層で十分であり、過剰な処理は逆効果となる。




右の上図は、HMDS処理時間に伴う純水接触角の変化を示している。サンプルは代表的な半導体基板であるシリコンウェハを用いている。処理前のシリコンウェハの接触角は35°程度であるが、わずか数分のHMDS処理で接触角は70°まで増加し、その後、6時間かけて85°まで徐々に増加し飽和していく。実プロセスでは、数分間のHMDS処理時間で十分な効果が得られる。右の下図は、HMDS処理後の熱処理温度および時間依存性を示している。比較として、有機洗浄処理のみのシリコン基板のデータも示している。処理温度は50~300℃であり、処理時間は1分および5分間である。熱処理前の接触角は、有機洗浄後で35°であるが、HMDS処理後では85°となる。有機洗浄のみの場合は、熱処理温度の増加に伴い、接触角は徐々に低下している。これは、シリコン基板表面に薄い酸化膜が形成されることによって、純水の濡れ性が増加することを示している。一方、HMDS処理後に実施した約120℃で1分間の熱処理によって、接触角は100°近くとなり最大を示している。よって、HMDS処理後の熱処理温度に最適値が存在する。この熱処理温度は、HMDSの沸点に近いことが特徴的である。HMDSの沸点近くで熱処理することで、試料表面に過剰に残存していたミスト状のHMDSを気化し除去できる。これにより、シリコン酸化膜表面に、単分子のシランカップリング層が形成できる。しかし、さらに高温の熱処理を行うと、疎水基の熱分解が生じるため、その効果は低減するとともに、熱酸化膜の成長が促進し純水接触角は低下してくる。また、5分間の熱処理では、接触角の最大値が見られず、有機洗浄と同程度まで接触角が減少している。これも、過剰な熱処理でシリコン酸化膜の成長が促進したことが理由である。以上のように、HMDS処理後の熱処理温度と時間には、疎水化処理の品質に大きく影響を受けるため、プロセス装置の構成には十分な検討が必要となる。


上図は、実用化されているHMDS気化器の原理図を示している。気化方式には、バブリング方式と減圧方式がある。どちらも耐腐食性の高いSUSチャンバーを用いる。チャンバーの容量は、10~100リットル仕様のものが多い。タンクの断面積が蒸発面積となるため、液面高さの管理は重要となる。上表には気化方式の特徴をまとめている。比較のために、初期に用いられていたHMDS原液の滴下スピン方式も記載している。HMDSの処理量を抑え、単分子層のHMDS処理を行うには、減圧方式が有利である。実用機では、処理効率を上げるためバブリング方式が採用されている。

また、上表には、HMDS処理シーケンスの特徴をまとめている。また、HMDSはバイトンなどのシール材料を膨潤させるため注意を要する。耐薬品性の高いカルレッツなどのパッキンを使用する必要がある。

上図には、代表的なHMDS処理装置のユニット構成を示している。これらの処理シーケンスには、処理速度、処理均一性、装置の小型化などの条件が反映されている。脱水ベークは、基板表面に吸着している水蒸気ミストを蒸発させることを目的とし、シーケンスの最初に行う。単分子化ベークは、カップリング反応を促進させ余剰なHMDSミストの除去を目的としている。気化器で発生させたHMDS蒸気を、効率良く基板全面に暴露させるには、蒸気流れのコンダクタンスを高めるように、配管径や減圧による圧力差を設計する必要がある。ユニットを減圧系に設計すると、ガスの平均自由行程が高くなり処理均一性を向上させることができる。下図は処理チャンバー内の処理シーケンスを示している。HMDS蒸気の処理前後には、チャンバー内をN2あるいは乾燥空気(DA)で置換する。これにより残存するアンモニアガスを除去できる。

参考文献
- Akira Kawai, Junko Kawakami, "Wetting analysis of hydrophobic substrate treated by HMDS primer", J. Photopolymer Science and Technology, 20, 815-816 (2007).
シランカップリング処理と密着性及び付着性
シランカップリング処理は、一般に、基板の表面エネルギーの極性成分を低下させる。このため、基板上に付着した薄膜や微粒子などの溶液中での密着性を改善できる。これは、拡張係数Sによる円モデルで説明できる。下の左図は、HMDS処理を行ったシリコン基板の表面エネルギー成分図を示している。25秒までの短い処理であるが、HMDS処理に伴ってシリコン基板の極性成分が減少する。そして、コーティング材料である樹脂(レジスト)の成分値へ近づいていく。下の右図は拡張係数Sに基づく円モデル表示をしている。HMDS処理により、基板とレジストとの成分値を直径とする円が縮小していく様子が分かる。これにより、純水の成分値は円から離れており、HMDS処理したシリコン基板とレジスト膜との界面へは、純水が浸透しなくなることが分かる。


下表および下の左図には、拡張係数Sの値を示している。比較のために付着仕事Waも示している。HMDS処理時間の増加に伴い、拡張係数Sは正の値で増加することが分かる。すなわち、シランカップリング処理することで、界面への水の浸入を防止できる(密着性)ため、塗膜の耐久性に大きく効果がある。下の右図は微細高分子パターンの剥離状況の電子顕微鏡写真を示している。これは、パターン現像時のリンス中に基板界面への純水の浸透によって生じた剥離不良である。この基板にHMDS処理を行うと、このようなパターン剥離が改善されて、密着性が向上することとなる。




レジストパターンの付着力解析
このように、シランカップリング処理による表面エネルギーの低下に伴い、基板とコーティング膜との密着力は改善する。しかし、コーティング膜と基板の界面付着力は低下することとなる。ここで、密着力と付着力との定義の違いに触れておく。一般的に、密着力は溶液などの界面浸入を防ぐシーリング能力である。付着力は界面を形成する2表面間の引き合う力である。上の左図に示したように、シランカップリング処理では、液体中での固体間の密着性(拡張係数S)は改善されるが、基板上の固体の付着力(付着仕事Wa)は低下させる。逆に、酸素プラズマ処理のように、固体と基板との物理的な付着力は高くするが、溶液に対する界面の密着性は低くなる場合もある。ここでは、右図に、原子間力顕微鏡(AFM)を用いた微細レジストパターンの付着力の測定方法を示している。AFMを用いることで、このような微細パターンの剥離力(N)を定量化することができる。下の左図には、実際にAFMの探針を用いて、直接剥離させたレジストパターン像を示している。この場合のHMDS処理時間は10秒から25秒間である。微小なレジストパターンが慎重に剥離されている様子が確認できる。そして、下の右図は、HMDS処理時間とレジストパターンの付着力との関係を示している。HMDS処理時間の増加に伴い、パターンの付着力は低下することが分かる。このように、大気中でのレジストパターンと基板間の付着力は、HMDS処理によって弱められることが実験的に確認できる。シランカップリング処理剤としてHMDSに注目し、密着および付着特性などを概説した。特に、実際の半導体LSI、液晶パネルおよび太陽電池パネル製造工場で適用されている装置およびプロセスに注目した。シランカップリング処理により、基板の表面エネルギーの極性成分が低下し、密着性は向上する。しかし、コーティング膜と基板との付着力は低下する。ここでは、コーティング膜の安定性コントロールにおいて、シランカップリング処理の有効性を示した。


付着力との関係
参考文献
- Akira Kawai, Takato Abe, "Direct Measurement of Resist Pattern Adhesion on the Surface with Silane-coupling Treatment by Atomic Force Microscope (AFM)", J. Photopolymer Science and Technology, 14, 513-518 (2001).
- Akira Kawai, Junko Kawakami, "Characterization of SiO2 surface treated by HMDS vapor and O2 plasma with AFM tip", J. Photopolymer Sci. Technol, 16, 665-668 (2003).
- Akira Kawai, Daisuke Inoue, "Van der Waals interaction between Si substrate and micro tip apex treated with hexamethyldisilazane (HMDS)", J. Adhes. Soc. Technol. 39, 255-258 (2003).
- Akira Kawai, Junko Kawakami, "Wetting analysis of hydrophobic substrate treated by HMDS primer", J. Photopolymer Science and Technology, 20, 815-816 (2007).